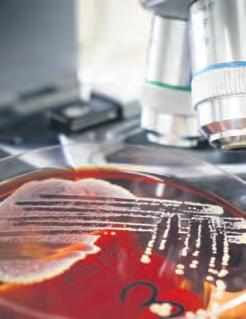

Overstyrmann Siv (27) har full kontroll ved roret Side 8-9 Hav av moglegheiter Magasin om fiskeri og havbruk i Sogn og Fjordane. Gitt ut av Fjordenes Tidende og Firdaposten i november 2022
Havlandet set nye rekordar
EIT HAV AV MOGLEGHEITER
Dette årlege sjømatmagasinet er det 20. i rekka frå Fjordenes Tidende i Måløy og Firdaposten i Florø. VI som til dagleg konkurrerer om å vere først med lokale nyhende i overlappande dekningsområde, ser heilt klart at vi saman kan lage eit betre og meir komplett produkt.
Magasinet er laga av redaksjonane i Firdaposten og Fjordenes Tidende.
Ansvarlege redaktørar: Håvar Fagerli, Fjordenes Tidende.
Svend Arne Vee, Firdaposten
Journalistar:
Arve Olav F. Solbakken
Egil Kristian Aardal
Dag Nesbø Frøyen
Liv Standal
Svend Arne Vee
Kjellrun Åsebø
Marianne Solheim Rotihaug
Gjert Myrestrand
Bjørn Erik Drabløs
Svanhild Breidalen
Epost:
Firdaposten: redaksjon@firdaposten.no
Fjordenes Tidende: fjt@fjt.no
Prosjektleiar: Rune Henden
Marknadsansvarlege:
Kim-André Gangeskar, Fjordenes Tidende Hanne Lid, Firdaposten
Formgjeving: Gunnar-Arne Haaland, Grafisk Bi-inntekt
Opplag : 4650 eksemplar
Trym blir første fiskaren i familien.
– Eg ser fram til å få på sjøen og kjenne
florø: Trym Hillersøy har ingen fiskarar i familien, men det er akkurat det han vil bli.
Trym Hillersøy frå Florø er ein av dei 12 elev ane som går på fiskerifaglinja i Måløy dette året. Dermed var han ein av dei Fiskarlaget trefte i samband med årsmøtet i Florø 5. oktober. Skulen har nemleg inngått ei fem årig avtale med Havforskingsinstituttet om eit årleg forskingstokt der elevar er med, og der skulen sitt eige autolinefartøy MS «Skulebas» blir brukt på eit tokt på inntil 25 dagar kvar haust.

– g jekk eit lys opp for meg
Trym syntest det var artig å vere på tokt, men seier at han først etterpå skjøna kva dei var med på.

– Forskinga opplevde eg mest som gøy. Det gjekk eit lys opp for meg då eg såg nyheita om at det blir opna for fiske av pigghå. På årsmø tet i Fiskarlaget fekk vi mykje skryt frå erfar ne fiskarar, og fekk høyre kor viktig dette var. Så då gjekk det opp for meg kva vi faktisk har gjort.
For dette er nemleg resultatet av forskinga deira: For første gong sidan 2009 blir det opna for pigghå-fiske i Nordaust-Atlanteren. Vel 17.000 tonn kan fiskast dei to neste åra.
Trym har alltid vore interessert i fiske, for tel han, men det er ikkje heile grunnen til at han valde det som yrkesveg:
– Det er også ei god hjelp er at det er ganske gode pengar i det. Men eg likte det allereie då eg var liten, eg har alltid synest det har vore spennande å fiske. Vi har hytte på Fanøya og eg har både vore med bestefar og fiska og også halde på sjølv.
Trym starta først på TIP i Florø, så ombe stemte han seg og starta på naturbruk i Mål øy året etter. No går han på vg2 fiske og fangst.
Har treft bra

– No har du starta på andre skuleåret, og du har vore med på tokt. Kva tenker du om yr kesvalet ditt så langt?
– Eg trur eg har treft bra, seier han sindig.
– No skal vi ut i læretida, to år på båt, og eg
ser veldig fram til å få erfaring på sjøen, tene min eigne pengar... Ha litt friheit og kjenne på vaksenlivet! smiler han.
Førebels veit han ikkje kva båt han skal på, men han har sine mål, som han seier.
– Eg vil på ein båt som driv enten med auto line eller garn. Eg likar korleis dei båtane driv, og korleis fisket går føre seg.
Han er klar over at livet hans vil bli annleis enn dei fleste av kompisane sitt. Medan dei går på jobb kvar dag, vil han jobbe intensivt når han er om bord, og deretter ha lange fri periodar.
– Det eg tenker om det, er at eg har ein god del hobbyar. Ein må jo prøve å halde på med noko når ein er heime. Og eg likar å skru og køyre båt, halde på med bil og vere saman med kompisar. Eventuelt fiske litt når ein er heime på fritur.
– At du også vil bli mykje vekke, det plagar deg ikkje?
– Ikkje i det heile. Vi var ute i fire veker med «Skulebas» no, og eg treivst veldig godt.
lofotfiske over nyttår
Gjennom tidlegare tider har fiskaryrket ofte gått i arv frå far til son - eller dotter, i våre da gar - men no er det mange i Trym sin klasse som ikkje har fiskarar i familien. Han trur nok lønna er ein faktor også for mange av dei andre, men ikkje berre.
– Eg legg merke til at alle har ei interesse for faget, med fiskeriet og spenninga i det, og kor kjekt folk synest det er.
Trass i at dei no er tilbake på skulebenken, er det framleis dagar på sjøen å gle seg til.

– Det blir teori ut året, og etter nyttår skal vi på Lofoten og fiske etter torsk med garn i tre veker med «Skulebas». Det ser eg veldig fram til, då får vi prøvd oss på garn også.
Elevane får også erfare den evig pågåande jobben med å halde fartøyet i topp stand. «Skulebas» er meir enn 40 år gammal, og nytt fartøy er på veg. Men enn så lenge blei til dø mes turen til fiskerimessa i Trondheim brukt til å pikke rust og generelt gå over skuta.
– Det er ein båt frå 1970-80 talet, og det legg ein merke til. Men det går fint, den er pussa opp i høve kva den var, seier den unge, kom mande fiskaren.
Liv StandaL
2 Hav av moglegHeiter 2022
meir
side 4-6
les
om desse sakene: Desse studentane har svært gode jobbutsikter
s ide 38-39
gjerne ser fleire av
s ide 16-17
«Rebekka L» får merksemd frå dei reiarlaget
på havet
Fot o: e
Fiskeri Faglinja i m åløy: MS «Skulebas» er skulen sitt eige autolinefartøy.
rling Wåge
få erfaring kjenne på vaksenlivet!



3 Hav av moglegHeiter 2022
F i SK ar i N SP e : Trym Hillersøy frå Florø går vg2 fiske og fangst på Måløy vidaregåande skule. Han fortel at han har likt å vere på sjøen og fiske frå han var liten, men at det også er ein motivasjon av fiskarar tener gode pengar. F oto : g jert m yre S tra N d/ Fjorde N e S t ide N de Laks og ørret av høy kvalitet. Barnslig godt, helt enkelt. A til Å www.atilaa.no bravoseafood.no
Desse studentane skal dekke kompetansebehov i maritim

Måløy: Fagskulen Vestland si avdeling i Måløy speler ei viktig rolle i å utdanne maskinoffiserar til ei maritim næring som nærmast skrik etter fleire maskinistar. Emma Røys (20) frå Bremanger ser for seg offshorenæringa som sin framtidige arbeidsplass.
Det var ei stund ho ikkje såg ruta så klart. Etter ungdomsskulen var hos usikker på kva retning ho skulle velje.
– Eg var veldig usikker på kva eg ville. Eg tok utgangspunkt i ting eg var interessert i, og i hobbyane mine. Eg har alltid vore veldig glad i å vere ute på sjøen og fiske i lag med far min. I tillegg er eg den typen som er interessert i å finne ut kor leis ting fungerer og er sett saman, seier Røys, som valde teknologi- og industrifag første året på vidaregå ande, før ho tok spesialisering i ma ritim retning andre året.
Det tredje og fjerde året var ho lærling i maskinrommet på to ulike skip hos offshorereiarlaget Olym pic.
– Eg likte meg veldig godt der, spesielt på ankerhandteringsbåten. Når eg er ferdig utdanna kunne eg godt tenkt meg tilbake dit. Men eg er ikkje låst til offshorenæringa – eg kan gjerne prøve andre ting også, smiler ho.
– vi har studentar som veit kva dei vil
– Det er spesielt maskinistar det er stor mangel på ute i dei maritime næringane. Vi klarer ikkje å dekke etterspurnaden med det talet stu dentar vi har i dag, seier Lars Berle,
leiar ved Fagskulen Vestland si ma ritime avdeling i Måløy.
I august tok dei imot eit nytt kull med maskinoffiserstudentar.
Nesten alle som blir tatt opp på studiet har bakgrunn som skips motormekanikar med fagbrev. Det vil seie at dei allereie har vore på sjøen i to år som lærlingar etter ei toårig maritim motorutdanning frå vidaregåande skule.
– Det at studentane har vore på sjøen før dei kjem til oss gjer at dei veit kva dei går til, i motsetnad til dei som går rett til ei treårig høgskule- eller universitetsutdanning utan praksis frå livet om bord i ein båt. Eg meiner dette gir studentane våre ein stor fordel, og vi ser det igjen i motivasjonen og læreviljen deira. Dei veit kort sagt kva dei vil, seier Lars Berle.
– d et viktigaste er å ha ein jobb ein trivst med Henrik Rønhovde (20) frå Måløy fortel at grunnlaget for utdannings valet hans blei lagt i oppveksten.
– Eg har vakse opp med sjø og båt og alltid hatt ei spesiell interesse for motorar. Det at det er mangel på maskinistar har vore mykje fram me i media dei siste åra, men det var eigentleg ikkje viktig for meg. Det er jo kjekt å vite at ein truleg
kan gå rett i jobb, men det er endå viktigare at ein får jobbe med noko ein trivst med.
Henrik har gått same løpet som Emma, og dei gjekk i same klasse dei to åra på Måløy vidaregåande skule.
I tida som lærling gjekk Henrik to år som lærling på Frøyanes Senior og Kapp Farvel.
– Og så jobba eg eitt år som mot ormann. Eg ser nok for meg å jobbe på ein fiskebåt når eg er ferdig på fagskulen.
– l ærarane «slepar» deg gjennom studiet
Tobias Torvik er frå Fosnavåg og hadde lagt bak seg ni år som servi cemekanikar på båtar i selskapet Ulmatec Skipsservice AS på heim plassen før han bestemde seg for å ta fagskuleutdanning. Han er heilt tydeleg på kvifor han valde Måløy som studiestad.
– Det gjorde eg på grunn av det gode ryktet som denne skulen har.
Her «slepar» lærarane deg gjennom studiet, enten du vil eller ikkje, sei er Torvik med eit smil, og held fram:
– Studiet krev sjølvsagt ein solid eigeninnsats, men eg føler lærara ne gjer alt dei kan for at vi skal be stå. Dei stiller til og med opp på
4 Hav av moglegHeiter 2022
g ode utsikter: Matias Aare (t.v.), Henrik Rønhovde, Tobias Torvik og Emma Røys set pris på at jobbutsiktene etter enda studium er gode. alle F oto : g J ert m Y restra N d
dekke eit skrikande maritim næring

kveldstid om det er behov for det. – d et er alltid behov
for ein maskinist
For måløyværing Matias Aare star ta interessa for motorar med at han begynte å skru på bilar saman med far sin.
– Eg lærte mykje om motorar, men fann ut at eg ikkje ville bli bil mekanikar. Eg hadde meir lyst til å fare «på sjynn». Det er alltid behov for ein maskinist. Aller helst vil eg jobbe på ein snurpar. Det er mange om beinet og lite utskifting av folk på desse båtane, men med genera sjonsskifte opnar det seg kanskje
ein moglegheit, seier Aare, som har vore lærling på Babord Catch sine båtar Gambler og Andrea L i to år. Avdelingsleiar Lars Berle er heilt einig med Matias.
– Det er heilt rett. Det er alltid be hov for ein maskinist. No håper vi fleire vel denne utdanninga. Vi har plass til fleire studentar, ikkje minst når nybygget står klart her på Ten nebø, kanskje allereie ved starten av skuleåret 2024/2025, avsluttar Berle.
GJERT MYRESTRAND
auka satsing: Rektor Torbjørn Melstad (t.h.) i Fagskulen Vestland seier at både politikarar, styret og han sjølv er einige om at fagmiljøet i og rundt Måløy tilseier ei auka satsing på Måløy-avdelinga, inkludert etablering av nye studiar i marine fag. Frå venstre: Lars Berle, leiar ved Fagskulen Vestland si maritime avdeling i Måløy, Administrativ leiar Inger Vedvik Nygård ved fagskulen og Torbjørn Mjelstad, rektor. F oto : g J ert m Y restrand
– Vi satsar i Måløy. Fagmiljøa må ligge der det skjer
Fagmiljøa må ligge ute der dei finst og der det skjer, seier rektor Torbjørn Melstad ved Fagskulen Vestland.
– Det er sikkert mange som har vore usikre på om sa manslåinga av Fagskulen Sogn og Fjordane og Fagsku len Hordaland skulle føre til ei sentralisering, der fleire studiar blir samla i Bergen. Det ville eg sikkert sjølv tenkt om eg hadde jobba her, men det er ikkje slik vi tenker. Fagmiljøa må ligge ute der dei finst, seier han. – Vi har nyleg etablert eit studium i handverksysting. Det ligg i Aurland, fordi Aurland er best i landet på det te. Når vi no satsar 45 millionar på å bygge eit heilt nytt bygg til måløyavdelinga er det eit tydeleg signal om at vi satsar. Og det heng heilt klart saman med den lokale maritime og marine kompetansen her.
meir plass betyr fleire studium Rektoren peikar på at Fagskulen Vestland er størst i landet på maritime fag, og at meininga er at dei ulike linjene skal komplettere kvarandre.
– Vi har nesten 200 studentar i desse faga, fordelt mellom Måløy, Bergen og Austevoll. Studiestadane kan samle sett gi eit komplett tilbod. I Austevoll har vi RAS-utdanning, som handlar om drift av lukka opp drettsanlegg.



Utvidinga av bygningsmassen i Måløy gir skulen flei re og større klasserom som igjen kan opne for å starte fleire studium innan marine næringar, fortel rektoren.
– Det kan for eksempel vere eit havbruksteknikar studium eller eit studium i havbruksleiing.
Han meiner ein må unngå å krangle internt om kva studium som skal ligge kvar.
– Eg meiner det ligg store moglegheiter i å trekke vekslar på dei lokale fagmiljøa langs vestlandskysten. vil auke fleksibiliteten for studentane
Fagskulen Vestland skal utfordre den tradisjonelle strukturen i dei maritime utdanningsløpa.
– Utdanningane våre er toårige, og studentane våre er heiltidsstudentar. Vi kjem til å utfordre denne mo dellen for å gjere det meir attraktivt å velje fagskuleut danning. Her ser vi på moglegheiter for å kunne kom binere studium med jobb og legge betre til rette for studentar som får barn. Føresetnaden er at denne flek sibiliteten ikkje skal gå ut over kvaliteten.
Fagskulen ønsker at fylket opnar for fleire vgs-klasser
5 Hav av moglegHeiter 2022
Fagskulen v estland: Avdeling Måløy .
s amansveisa: Etter knappe tre månadar som studentar er dei kommande maskinoffiserane som starta i haust etter alt å døme ein godt samansveisa gjeng. Her er 10 av dei 11 førsteårsstudentane.
F oto : g J ert m Y restrand
n aturtru: Det andre året i studiet blir cirka 20 prosent av tida brukt i den store skipsmaskinsimulatoren på fagskulen. Den gir ei naturtru oppleving av eit moderne motorkontrollrom. F oto : g J ert m Y restrand
Fagskulen ønsker at fylket opnar for fleire vgs-klassar
Måløy: Studentane som går ut frå Fag skulen Vestland si maritime avdeling i Måløy har kompetan se som er svært etter spurt. Med nytt skule bygg til 45 millionar på veg håpar skuleleiinga at fylket opnar opp for fleire maritime klassar ved Måløy vidaregåande skule.
Joakim Refvik, Steffen Heggøy og Kurt Røyseth Seime er alle klar over at det er liten sjanse for å gå ar beidsledig som uteksaminert dekksoffiser frå fagskulen på Ten nebø ved Måløy.

Sjølv om jobbtryggleik er viktig, er det interessa for livet på sjøen som er fellesnemnar for utdan ningsvalet.
– Eg har jobba som fiskar i femseks år. Med tida har eg sett at eg li kar meg på sjøen. Eg fann ut at eg ikkje berre vil gå på dekk resten av livet. Eg ville gjere noko meir og noko anna. Det er så mange mog legheiter til å komme seg opp og fram med ei fagskuleutdanning, seier Joakim Refvik (29) frå Måløy.
Steffen Heggøy frå Atløy og Kurt Røyseth Seime frå Hovden i Breim er også ferdig utdanna dekksoffi serar til sommaren 2023.
– Eg er oppvaksen i ein fiskarfa milie. Det er liksom fiskeri som har vore tingen. Eg har vore mykje i båt og på fiske, og gjekk læretida mi på vidaregåande om bord på to for skjellige fiskebåtar. I tillegg har eg hatt ein sjark og drive litt sjølv. Eg har tenkt litt på kor eg ønsker å job be. Eg satsar nok på å stå i styrehu set på ein fiskebåt. Det er nok der eg vil føle meg mest heime, seier Heg gøy.
Kurt Røyseth Seime hadde ei gentleg tenkt å bli elektrikar.
– Det er litt tilfeldig at eg hamna her på fagskulen i Måløy. Eg skulle eigentleg bli elektrikar, og gjekk elektrolinja ved Eid vidaregåande
skule. Eg fann ut at eg ville noko anna, og bytta til VG2 maritime fag ved Måløy vidaregåande skule. Et ter to år som lærling, eit år på sup plybåt og eit år på eit ankerhandte ringsfartøy, gjorde eg litt undersø kingar og fann ut at det å bli dekks offiser høyrdest spennande ut. Når eg er ferdig her, vil eg gjerne bli styrmann på eit offshorefartøy.
– Unike moglegheiter for høgare utdanning lokalt
Administrativ leiar Inger Vedvik Nygård ved fagskulen peikar på moglegheitene som opnar seg i og med at Vestland fylkeskommune har vedteke å bygge eit nytt og stør re bygg til fagskulen. Her får fags kulen eit eige bygg, der studentane får betre fasilitetar separat frå Mål øy vidaregåande skule.
– Då håpar vi at vi også kan starte opp nye linjer. Vi har godkjenning for studiet Leiing i havbruksopera sjonar, men har rett og slett ikkje plass til å starte opp dette studiet i dei lokala vi har i dag, seier ho.
– Stor etterspurnad
Skulesenteret på Tennebø, med vi daregåande skule og høgskule på same område, kan bli eit kraftsen ter innan maritime og marine fag utdanningar, trur ho.
– Det er ein veldig etterspurnad etter både dekksoffiserar og mas kinoffiserar i jobbmarknaden. Vi på fagskulen skulle ønskt at fylket oppretta fleire maritime klassar ved Måløy vidaregåande skule. Med
kombinasjonen vidaregåande sku le, lærlingordningar og den mariti me fagskulen kan lokal ungdom ta heile utdanningsløpet sitt i Måløy og ende opp i godt betalte jobbar, ofte med gode turnusordningar, seier Vedvik Nygård og legg til:
– Vi må heller ikkje gløyme at den nye opplæringsbåten Skulebas kjem til Tennebø neste haust. Den vil bety mykje for både Måløy vida regåande skule og for våre studium ved fagskulen.
Bedriftene får ikkje nok lærlingar
John Heimvik, som er leiar for Opp læringskontoret for fiskeri- og hav bruksnæringa (OKFH) i Måløy, stadfestar bildet av ei næring som nærast skrik etter folk.
– Fleire bedrifter har ein veldig bevisst strategi på å ta imot lærlin gar innan fleire fagområde. Lære bedriftene våre spør etter både maskinistar, styrmenn, matrosar og fiskarar, og etterspurnaden er mykje større enn det vi klarer å le vere.
Etterspurnaden etter lærlingar er større enn tilbodet.
– Vi ville raskt kunne finne lær lingplassar til ei ekstra klasse elevar frå maritime fag ved Måløy vidare gåande skule, som etter læretida vil vere kandidatar til å søke opptak ved fagskulen.
Gjert Myrestrand
6 Hav av moglegHeiter 2022
Joakim, Steffen og Kurt er «garantert» jobb:
g ode U t S ikter til jo BB : Joakim Refvik, Steffen Heggøy og Kurt Røyseth Seime utdannar seg til dekksoffiserar ved Fagskulen Vestland, avdeling Måløy.
Til sommaren går dei ut i ein arbeidsmarknad som jaktar kompetansen deira.
F oto : gjer t m Y re S tra N d


7 Hav av moglegHeiter 2022 Kom til Fiskeværet Kalvåg! Næringsareal på 22 000 kvm ledig for deg og di bedrift. Kalvåg er eit fiskevær på øya Frøya i Bremanger kommune i Vestland. Kalvåg ligg ytst i havgapet og er eit viktig fiskevær med fiskemottak, foredling, eksport, service, handel osv. Ledig næringsareal er tilrettelagd for hav- og fiskerinæringa og er knytt opp mot kommunale kaier. Plassering Plassering Kalvåg er eit fiskevær på øya Frøya Bremanger kommune i Vestland. Kalvåg ligg ytst i havgapet og er innafor ein 45-minuttsregion (45minuttsregionen.no). Kystvegen Måløy – Florø vil knyte saman kommunane Bremanger, Kinn og Sunnfjord til ein felles bu- og arbeidsmarknadsregion med om lag 50 000 menneske. 45-minuttsregionen gir maksimalt 45 minutt reisetid mellom dei ulike sentra regionen. Kalvåg - opplevelser i havgapet Kalvåg er eit viktig fiskevær med fiskeomsetnad og -foredling. Du finn eit stort mangfald av turløyper og ramsalta opplevelser høgt og lavt i havgapet – Hornelen, Vingen, Ålfotbreen, Grotle og Vetvika I gangavstand rundt den vesle vågen finn du Knutholmen. Her er det rorbuer, rom eller leilegheiter, restaurant, pub, dansegolv og møterom.
skape
av nordlege
Vestland
Kalvåg Bergen Trondheim Ålesund
Kystvegen Måløy – Florø, også kalla 45-minuttsregionen, vil
vekst på kysten
del av
fylke.
Frå brua på det 82 meter lange har overstyrmann Siv (27) full
Måløy: Frå brua på «Polfoss», Eimskip sitt 82 meter lange contai nerskip, har overstyr mann Siv Oldeide full kontroll. – Fjæra var min leikeplass då eg var lita. Det er ikkje overraskande at eg hamna i eit maritimt yrke, seier 27-åringen som bur i Holvik i Kinn kommune.



Ho har alltid vore glad i sjøen. Som lita var ho med faren Stig Oldeide på fiske til både Murmansk og Dan mark, og som tenåring tok ho båt lappen og køyrde heller eigen båt til Måløy enn buss. e lskar å segle langs kysten Sjølv er ho ikkje spesielt overraska over at ho hamna i eit maritimt yrke eller at ho er einaste kvinne i eit mannsdominert miljø. Men kanskje overraskar det andre å sjå ei kvinne ved roret. Oldeide har nemleg berre vore på éin tur der ei anna kvinne også var om bord.
– Sjølv tenker eg eigentleg ikkje over at eg jobbar berre med menn bortsett frå når folk påpeikar det. Mine interesser har aldri vore det ein ofte tenker på som stereotypis ke jenteinteresser. Og eg har alltid gått godt overeins med karane, sei er ho.
Ho er veldig glad i jobben sin. Mest av alt elskar ho å segle langs kysten.
– Det er som å reise på ein road trip gjennom eit fantastisk land skap som tar pusten frå deg. Det er spesielt flott når det er fint vêr. Du kosar deg og nyt utsikta, smiler ho.
«Polfoss» går i rute til Russland,
ned heile norskekysten til Eger sund, så til Nederland, England og av og til til Skottland.
12-timarsskift
Ein vanleg dag på jobben for Oldei de er eit 12-timars skift.
– Eg står opp klokka 01.45, et meg ei brødskive og så går eg opp på brua og tar over for skipperen viss vi seglar. Eg har seks timar med se glas, manøvrering og laste- eller losseoperasjonar. Viss vi ligg til kai og held på med lasting eller lossing, går eg på dekk eller ned i lasterom met. I lasterommet tar eg inn lasta frå land, har all kommunikasjonen med dei på land og kontrollerer las ta, forklarer ho.
Båtane Siv har vore på er refeerog containerbåtar eller lastebåtar.
– Vi har fem store lasterom der vi har moglegheit til å sette på både frys, kjøling og varme.
Dei fraktar mest frosen fisk, fis kefôr og salt.
– Men vi fraktar også alt ein kan sette på ein palle og løfte med ein truck eller med ei kran. Vi plukkar for eksempel med oss mange båtar. Det kan vere at nokon treng å få frakta sjarken sin frå Vestlandet til Finnmark, for eksempel om dei sjølve har tid til å køyre opp eller
ser det som meir effektivt å sende med oss.
– Friturane er heilage
27-åringen legg ikkje skjul på at ho også er glad i friturane.
– Friturane er heilage. Eg er seks veker om bord, men så er eg også heime seks veker i strekk. Då har eg fullstendig fri heile døgnet til å gje re akkurat det eg vil når eg vil, smi ler ho.
Når ho er heime, bur ho ikkje langt frå bygda ho voks opp, Kulen i Deknepollen. Der kan samtalene rundt kjøkkenbordet fort dreie seg om livet på havet.
– Pappa har vore skipper og jobba på havet i mange år. Så det blir ein del samtaler om nye og gamle fry seterminalar eller fiskemottak langs kysten. Vi kan også snakke om manøvrering i dårleg vêr. Og mamma har jo vore gift med ein fis keskipper i mange år, så ho har også god innsikt, både i seglas og det tekniske, smiler Siv.
Ha respekt for yrket
Oldeide har eit råd til alle som vil bli styrmenn eller skipperar.
– Det er viktig å vere litt audmjuk og ha respekt for det ein driv med. Det er ikkje flaut å spørje om hjelp –
8 Hav av moglegHeiter 2022
på brua: Her sit Siv Oldeide (27) på brua på Polfoss, det store reefer- og containerskipet ho er overstyrmann på. F oto : pr ivat
Stor båt: Overstyrmannen blir ganske liten på kaia framfor skipet ho fører. F oto : pr ivat
l a St: Her plukkar «Polfoss» opp ein båt dei skal frakte vidare. F oto : pr ivat
kontroll
Ditt båthotell! Kinn Marina tilbyr et moderne og effektivt kaiområde, som legger til rette for båthotell og vinteropplag. Vi har også fasiliteter for nødvendig service, vedlikehold og reparasjon.

Ta gjerne kontakt for et godt tilbud.
KINN MARINA

Adresse: Brandsøysundet 29, 6908 Florø Telefon: 485 06 000 / www.kinnmarina.no
lange lasteskipet kontroll
alle må starte ein stad. Og ein må vere førebudd på å ta dei arbeids
får og gjere alle dei
Håper på
fleire frivillige
Når Siv er heime er ho aktiv i red ningsselskapet. I august var ho sa man med kvinner frå åtte ulike land på teambygging i Finland.
– Vi skulle ikkje lære noko nytt. Berre øve og vere saman. Ingen av oss hadde møtt kvarandre før. Vi kom, fekk ein sandwich i handa, blei delt inn i lag, sett på båtane og køyr! Det var så sabla bra!




På samlinga diskuterte dei også kva ein kan gjere for å få fleire da mer inn i søk og redning. Noko ein treng.

– Det er veldig viktig, både at da mer vel det som yrke, men også som frivillig arbeid. Vi treng fleire som har lyst å vere med, seier ho og legg til:
– I Finland var det både sterkt og utruleg inspirerande å høyre andre sine historier frå lokale rednings oppdrag. Vi er mange kvinner som er frivillige i Redningsselskapet, men vi er ikkje mange nok.
Kjellrun Åsebø
Havlandet
Sammen med det det beste teamet driver vi verdensledende produksjon av torsk og berggylt
9 Hav av moglegHeiter 2022
l eikeplass: Denne fjæra var Siv sin leikeplass som lita. F oto : k J ellr UN Å se BØ
ko N toret: Ingenting slår utsikta frå «kontoret» til Siv. F oto : pr ivat
Deler er Fari N gar: – Vi har ikkje lagt oss borti yrkesvalet til Siv. Ho har gjort det ho ville. Men det er sjølvsagt kjekt å dele erfaringar. Eg har jo trakka opp og ned kysten i 30 år, så vi pratar om ein del plassar og ein del ting langs kysten som er spesielle og som andre folk ikkje kjem borti, seier faren til Siv, Stig Oldeide. F oto : k J ellr UN Å se BØ
oppgåvene ein
kjedelege tinga for å bli god, seier ho.
Florø: Området i Botnastranda aust om Norges største forsy ningsbase er no ferdig planert. Her kjem milliardsatsinga for slakting og foredling av oppdrettsfisk.

Slakteriet bygger nytt:
– Vi ser føre oss å vekse vidare
Slakteriet AS har no signert ein lei geavtale med Trondheimsfirmaet KMC Properties, som står for eta blering av bygget. Løpetida for av talen er på 20 år, med opsjon på ti års forlenging.
Selskapet sysselset i dag kring 170 personar, og omset årleg for rundt 200 millionar kroner. Planen er at ein i løpet av tredje kvartal 2024 kan opne nyanlegget i Florø, som skal sikre selskapet vidare vekst.
Hektisk haust
– I fjor haust starta vi samarbeid med Rambøl, som leiar prosjektet for oss. Vi har jobba intenst med å hente inn tilbod på bygg, maskiner, og alt av utstyr. Vi er midt i proses sen og jobbar no med vurderingar knytt til val av utstyr, fortel dagleg leiar Kristin Bergstøl Hansen når vi møter ho på bedrifta som i dag ligg midt i Florø sentrum.
KMC står for kostnadane knytt til eigedomen og bygga, mens Slakte riet investerer ein nesten like stor sum i maskiner og utstyr.
Til saman rundar dei milliarden i investeringar. Anlegget får ei større grad av automatisering, men det vil ikkje bli kutt i talet på tilsette.
Satsar på filetlinje
– Sjølv om slaktedelen vert betyde leg meir automatisert, har vi ar beidd med innfrysing og den nye fi letlinja som vi set i drift. Vi er i gang med å auke kompetansen til dei til sette og førebu innflytting i det mo derne foredlingsanlegget, seier Bergstøl.
Dei legg opp til same slaktevo lum, men dei vil kunne ta unna meir fisk samtidig, og liggetida for brønnbåtane kan gjerast svært
kort. Ein stor gevinst med nyanleg get er filetlinja, som gjer til at ein får tilnærma 100 prosent utnytting av råstoffet.
I tillegg får dei auka kapasitet til å ta imot fisk for innfrysing. Dei tek med seg dagens ventemerdar, der dei største båtane og kan legge til.
– Totalt sett vert det reduserte driftskostnader, noko som vil gjere oss meir konkurransedyktige. På miljøsida kjem vi styrka ut med re dusert energiforbruk, mindre ut slepp, som igjen reduserer smitteri sikoen, fortel ho.
Skatt og politikk
I ei tid med auka straumprisar, hø gare rentenivå og ei omlegging i skattlegginga av oppdrettsnærin ga, er det fleire aktørar i bransjen som set investeringsplanar på vent. Usikre tider påverkar ikkje storsat singa til Slakteriet, sjølv om dei er avhengige av jamn tilgang med fisk, frå blant anna lokale opp drettarar som er medeigarar i verk semda.
Høgreleiar Erna Solberg var nyleg
på valkampturné i våre trakter og fekk innsyn og første hands infor masjon frå ein bransje som no mei ner det auka skattetrykket vert for høgt. I Florø Hamn sitt nye lokale på Fugleskjærskaia, fekk dei høve til å legge fram sitt syn på fiskeri- og skattepolitikken viktige for lokalsamfunna – Min bodskap til Erna på dette mø tet handla om den verdiskapinga som vi bidreg med. Vi har til saman 100 årsverk i bedrifta. Det er alt frå ufaglærte, som kan vere asylsøka rar, til dei med høgare utdanning som flyttar til byen. Verdien av å ha store arbeidsplassar er betydeleg, forklarer Bergstøl. Det går store summar til lokale firma som leverer tenester til be drifta. Ho har eit sterkt ønskje om at det vert ein lokal profil på utbyg ginga, når ein er i mål med anbods konkurransen.
Har trua på vekst – Det er skapt ein stor usikkerheit den siste tida for sjømatnæringa.
Kor godt det skal gå framover, kjem an på den totale skattlegginga ein legg opp til. Det er vilje til å betale skatt, det er det ikkje tvil om. Faren er at ein ikkje vert i stand til å vere med på investeringar i slike pro sjekt som vi jobbar med no, seier Bergstøl.
– Skal vi vere levedyktige om 10 år, så er vi nøydd til å ta den inves teringa som vi gjer no. Eg ser for meg vidare vekst, med ei trinnvis utbygging. Kanskje har vi ei filet linje nummer to, og vi har fått fleire oppdrettarar med som kundar. Vi ligg jo sentralt til i Florø, noko som er gunstig.
Spår om framtida
Ein er i starten med etablering av landbasert oppdrett, og meir lukka anlegg. Ulike løysingar vert prøvd ut, og her skjer det for tida store ting lokalt i Florø. INC-Gruppen satsar tungt, med både torsk og et ter kvart oppdrett av laks. RAS-tek nikkar vert testa ut, og store areal på Fjord Base, er tiltenkt den nye næringa.

– Eg håpar og trur at om ti år, så er ein godt i gang med drift av landba sert oppdrett her i Florø, og elles i regionen. Trass i at føresetnadane stadig forandrar seg, så er eg opti mistisk. Lokale oppdrettarane har brukt mykje av overskota til å in vestere og utvide for framtida. Dei er hardtarbeidande og mange av dei finn du dagleg i arbeid på merd kanten, avsluttar ho.
egil kristian aardal
10 Hav av moglegHeiter 2022
Fot o:
a S
St Y r K a laget: Dagleg leiar Kristin Bergstøl Hansen har fått med seg Cicilie Færestrand som HR-sjef, på Slakteriet AS. F oto : e gil a ardal B
ot N a Stra N da : Slik vert Slakteriet AS sitt nye anlegg når det står klart i 2024.
Sla K teriet
~ Vi har fokus på å drive berekraftig og å ta vare på naturen og miljøet rundt oss. For å nå desse måla er vi heilt avhengig av at den tekniske sida fungerer.
FISK som har det godt – smakar godt
På nordsida av Hundviksfjorden – mellom Nord fjordeid og Sandane – ligg Eide Fjordbruk sitt opp drettsanlegg med økologisk laks. Desse laksane har det betre enn dei fleste, med meir plass, reinare fôr og mindre medisinering – og ein sikker teknologi, forsikrar driftsleiar Lars Gunnar Hammersland.
Fiskevelferd i kombinasjon med god teknologi er avgjerande for at vi kan gjere ein så god jobb som mogleg. Driftsleiaren på Hundvika peikar og viser korleis dei har full oversikt over livet nede i merdane via skjermane på arbeids- og fôrflåten. Arild Helle monterte det radiobaserte Enivest-sambandet til lokaliteten våren 2021, og set pris på at alt fungerer som det skal. Det kan vere friskt her, midt i kryssingspunktet mellom fleire fjordarmar, og dermed utfordrande å få eit stabilt nett.
Optimal nettløysing
Kapasitetsbehovet til oppdrettsnæringa har eksplodert dei siste åra. Sjur Gimmestad i Enivest, som har jobba tett i lag med Eide Fjordbruk for å finne den beste løysinga for i Hundvika, fortel at næringa er eit satsingsområde for dei. Til denne lokaliteten var det uaktuelt å få ut fiber, men vi har fått ei god løysing med ei internettnode og radiolink til fôrflåten.
Godt liv – god smak
Fisk som har det godt, smakar godt – er det enkle og viktige svaret på kvifor vi er avhengig av eit stabilt nett midt ute på fjorden, smiler Lars Gunnar. Vi har fokus på å drive berekraftig og å ta vare på naturen og miljøet rundt oss. For å nå desse måla er vi heilt avhengig av at den tekniske sida fungerer. Her på flåten er vi 3 personar med vanlege arbeidsdagar frå kl. 7 til 15, men vi må ha god kontroll med drifta også når vi ikkje er her. Dessutan driv vi i samdrift med andre lokasjonar – og då er det ekstra viktig med eit nett som gjer at vi kan fjernstyre anlegga saman.



Forskar på fôr Eide Fjordbruk, som har sitt opphav lenger sør i fylket – i Eikelandsosen – har satsa tungt i Nordfjord dei siste åra. Hundvika er eit av tre anlegg dei er involverte i. Naturen, hardt arbeidande menneske og teknologisk innovasjon har brakt dei dit dei er i dag – og slik skal vi fortsette å jobbe oss inn i framtida, fortel driftsleiaren. Anlegget her på Hundvika er ein FoU-konsesjon, der vi driv med forskingsarbeid på fôret. Målet er å ta heile næringa i ei meir berekraftig og helsefremjande retning.
Berekraft og teknologi hand i hand Enivest ser det som svært verdifullt å jobbe med eit selskap som tek miljøansvar, seier Gimmestad, og legg vekt på at Enivest kan vere med på å gjere dette arbeidet lettare. 95 % av klimaavtrykket frå norsk laks kjem nettopp frå fôr og fôrråverer, noko som gjer arbeidet til folka her i Hundvika ekstra viktig.
11 Hav av moglegHeiter 2022
enivest.no
Lars Gunnar Hammersland, driftsleiar Eide Fjordbruk
André (25)
er den einaste att på øya på sin alder: – Det er jobben som held meg her
Så fort han blei gammal nok, be gynte han å ta vakter på Mowi sitt anlegg Flåtegrunnen i Skorpefjor den, der far hans jobba.
– Det stemmer, det. Rett før eg fylte 16, bekreftar Bjørn André.
Tok ein omveg
Men han stifta kjennskap med næ ringa lenge før det. Han var med pappa på jobb i helgane og elles når det passa seg frå barnehagealder av og fram til 9-10 årsalderen. Då var det ikkje lenger lov for dei tilsette å ha med seg ungane på jobb. Men så fort han fylte 16 og kunne ta betalte vakter, var han som sagt på plass igjen.
– Har du alltid visst at det var i oppdrettsnæringa du hadde fram tida di?
– Nei, det er stikk motsett! Planen var noko heilt anna frå barndom men av; eg skulle bli tømrar. Så før ste året på vidaregåande byrja eg på bygg og anlegg, fortel han.
Men allereie etter eit halvt år skjøna han at tømraryrket eigent leg ikkje var for han likevel.
Så kva gjer ein då, når ein hoppar av midt i eit skuleår, 16 år gammal? Jau, då er vegen kort tilbake til kjende forhold, og på Flåtegrunnen tok dei mot han med opne armar fram til neste skuleår byrja. Og frå då av stod vel kursen beint mot havbruksnæringa?
– Nei! Då var draumen å bli styr mann. Så hausten 2014 å byrja eg på TIP i Florø, og året etter kom eg inn på maritim i Måløy.

Men så kom ein aktiv haustferie med Bjørn André i full sving med avlusing på anlegget.
– Og det hadde vore så kjekt, med mykje variert arbeid... Då kjende eg at det var dette eg ville drive med, fortel han, og dermed var det duka for det siste svingen i utdannings løpet: Han gjekk over på akvakul tur. Han hadde allereie karakterar i realfaga, så det einaste han trong var programfaga. Våren 2017 var han klar for lærlingtida. Då kom alle timane på Flåtegrunnen til nytte: Med så mykje erfaring frå yrket som Bjørn André hadde, fekk han nedsett læretid, så på forsommaren 2018 stod han med fagbrev i handa.
Han ser likskapar mellom det før ste yrkesvalet sitt, tømrar, og det han driv med i dag.
– Det er kjekt å sjå at ting blir til, og slik er det jo også i oppdrettsnæ ringa: Vi driv matproduksjon, og
det er givande i seg sjølv at du job bar med noko folk treng.
Påverkar miljøet på godt og vondt
Bjørn André er sjølvsagt fullt klar over kritikken mot næringa han har valt, der forskarar og miljøforkjem parar meiner at næringa har ein veg å gå i høve utfordringar med foru reining og dyrevelferd for laksen, mellom anna.
– Vi driv matproduksjon, og som mykje anna, påverkar vi òg områda og miljøet kring oss, både på godt og vondt. Men produksjonsmessig er lakseoppdrett den mest bere kraftige proteinkjelda vi har. Kar bonutsleppa er låge i høve matpro duksjon på land. Miljøundersøkin gar gjort på toppen av produksjons syklusen for å måle påverknaden på sjøen, viser at vi har god kon troll, men at ein kunne fått endå be tre kontroll i lukka anlegg. Nokre parameter har ein ikkje kontroll på i eit ope anlegg; algeoppblomstring, maneter som kan vere ein trussel, eller, slik vi har sett mange tilfelle av dei seinare åra - makrellstørje som har torpedert merdar og ført til rømming. Det ville aldri skjedd i eit lukka anlegg. Men eg er for den driftsforma vi har i dag. Skal alt oppdrett bli landbasert må store landområde nærast raserast. I til legg vil det krevje mykje energi, og med store deler av Europa i energi krise, er det inga god løysing slik si tuasjonen er i dag.
Han har heller ingen problem med å underbygge kvifor han mei ner det nylege forslaget frå regje ringa om ein grunnrenteskatt på 40 prosent for havbruksnæringa er feil.
– Dette er ei næring som er bygd opp stort sett på eigne bein, utan særleg bistand frå staten si side. Så at ein no skal inn og krevje tilbake enorme summar basert på tidlegare feilvurderingar, blir feil. At ein ikkje tok seg betalt for konsesjonar i star ten kan ikkje ha tilbakeverkande kraft i dag.
Åleine igjen på øya
– Det er fellesskapen sine areal som blir bandlagde til denne produksjo nen?
– Men det er oppdrettaren som står med risikoen. Målt mot tradi sjonelt fiskeri, så er båten den risi koen reiaren har medan han hentar opp ressursane. For oppdrett er det
utgifter og risiko heile vegen, frå rogn til filet - og det er mykje som kan gå gale undervegs. Det finst sjukdommar ein framleis ikkje har behandling mot, som ILA (infeksi øs lakseanemi, ein smittsam virus sjukdom, journ.anm.). Får ein det når fisken er for liten til å kunne slaktast, er einaste alternativet å destruere den. Då er det reint tap, det du har av utgifter vil du ikkje få dekka, slår han fast.
Men han ser på næringa rik på moglegheiter, og så lenge han trivst med arbeidet, meiner han at han har ein trygg og god arbeidsplass.
Han har busett seg i Rognalds våg, men er usikker på om det vil bli slik i framtida også.
– Eg er nok den einaste som har vakse opp her dei siste tjue åra som bur og jobbar her. Elles er folk flyt ta, og dei fleste fer til Bergen.
– Korleis kjennest det?
– Nei, det er jo mangelvare med folk på min alder, då. Snittalderen her ute er nok over 50 år.
– Det gir deg ikkje lyst å flytte, då?
– Jau, det gjer eigentleg det. Det er mest jobben som held meg her. Eg kan sjølvsagt flytte inn til Florø, men noko særleg lenger vekk enn det er ikkje så gunstig. Ein veit jo al dri, men sjansen for å finne seg ei å dele livet med her ute er ikkje så stor, erkjenner han.

Og då kan Florø vere eit alterna tiv.
– Dei fleste eg har vakse opp med har som sagt reist litt lenger sør over. Skulle det dukke opp jobbmo glegheiter andre stader, må ein sjølvsagt vurdere det òg. Men det ligg no litt inn i framtida.
Liv StandaL
12 Hav av moglegHeiTer 2022
Reksta: Trass sin unge alder, har Bjørn André Gjertsen (25) snart ti års fartstid i havbruksnæ ringa.
Bjørn
T il B a K e T il UTga N g SPUNKT e T: Trass i at Bjørn André Gjertsen jobba ved oppdrettsanlegget i Larsvika på Reksta frå han fekk lov, tok det litt tid før han fann ut at det var dette som skulle vere yrkesvegen hans. Men det kan vere einsamt å vere den einaste fastbuande på øya under 30 år, frårekna ei handfull barn. F o T o : o lav S T eimler
F l ÅT egr UNN e N: Bjørn André er ein av åtte fast tilsette på Flåtegrunnen. Anlegget er spesielt, fordi han har to kvinnelege kollegaer som er driftsteknikarar, pluss ein kvinneleg sjef på anlegget. Fo T o: l iv S Ta N dal










13 Hav av moglegHeiter 2022 selstad.no Vi kjenner havet Les mer på: www.marfo.no/ har-du-mista-noe Vi kan gjøre havet renere sammen Har du mista noe? Tonnevis av taustumper og små plastbiter havner i havet år etter år. Mye er mista til havs.
Natalia (39) har tatt steget opp:
– Det er kjekt med tilsette som seier ja!
Florø: – Hos oss skal det vere mogleg å bygge ei karriere. Vi er opptekne av haldningar og at våre tilsette er stolte og motiverte, seier HR-sjef Cicilie Færestrand. Ho kom nyleg inn som ei forsterking i administrasjonen hos Slakteriet AS.
At ho er stolt av jobben sin, kjem tydeleg fram når vi møter Natalia Kazantseva. For seks år sidan be gynte ho i produksjonen. No held Natalia til i administrasjonen, og har fått eit års erfaring i arbeidet med kvalitetskontroll og systema rundt dette.
g reip sjansen
– Eg hugsar godt då Cicilie kalla meg inn til medarbeidarsamtale. Då snakka eg blant anna om at eg ville lære meir. Eg har bakgrunn frå bilsal heime i Murmansk og har it-kunnskap. Då var det utruleg kjekt å få tilbod om ein kontor jobb, fortel Natalia.
Ho er ferdig med teoridelen til fagbrev Vg3 sjømatproduksjon. I fjor var dei 11 tilsette som sette seg på skulebenken, og før sommaren var det klart at alle hadde bestått teorien til fagprøva. Dei er no meldt opp til den praktiske prøva. – Eg er opptatt at vi leverer god kvalitet på produkta våre, for det jo mat vi produserer her. At mange utdannar seg, er med på å heve kvaliteten på arbeidet vårt, fortel ho engasjert.
Språk
og få meg norsk sertifikat. For å etablere seg å kome seg vidare er språket viktig. Det er mi erfaring.
Sambuarparet som kom til lan det for seks år sidan er no er dei blitt til ein familie på fire, som har slått seg til ro i kystbyen. Natalia smiler når ho fortel om korleis det har gått å etablere seg i eit nytt land.
Ny i byen
– Folk er så blide og hyggelege her, og det har gått greitt å bli kjend med naboar og kollegaer på bedrif ta, fortel ho.
– Det er kjekt å ha tilsette som seier ja, og som tek på seg nye opp gåver slik vi har opplev med Nata lia. Ho er ein fantastisk ressurs for oss, det er det ingen tvil om, seier Færestrand som har personalan svar i bedrifta.
No er det ekstra høg aktivitet. Dei har bemanna opp og jobbar to skift for å ta unna arbeidet. Ved behov nyttar dei seg av arbeidskraft frå bemanningsbyrå og lokal ungdom kjem inn som sesongarbeidarar.
Skryt til dei unge
er nøkkelen
Fleire av dei tilsette har utanlandsk bakgrunn, og på bedrifta har dei sett som krav at ein kan norsk eller engelsk. Dei har gjort nokre unn tak, og då kjem Natalia på bana som tolk. Å beherske det russiske og det ukrainske språket, kjem godt med når dei med flyktning bakgrunn skal inn i arbeidslivet. – Då eg kom til Norge var eg opp teken av å lære med språket fort,
– Eg vil skryte av ungdomen som jobbar hos oss i høgsesongane. Mange kjem igjen år etter år, og verkeleg står på. Har ein god ar beidsmoral kjem ein langt, noko som sjølvsagt gjeld for alle tilsette. Ein kan få seg ei fagutdanning i be drifta etter lang praksistid, noko som er positiv og styrkjer oss, seier Færestrand.
Dei har fram til no ikkje vore ei lærebedrift, men dette ønsker dei å snu på. Når dei om to år er i full
Vårt kompetente mannskap har lang erfaring fra bransjen, og leverer alltid tjenester av beste kvalitet med stort fokus på hygiene, miljø og sikkerhet.






www.aquaship.no

 Kristiansund | Førde | Skottland | Chile | Canada
Kristiansund | Førde | Skottland | Chile | Canada
SERVICE FEEDLIVE FISHUTILITYHARVEST 14 Hav av moglegHeiter 2022
Totalleverandør av innovative fartøy til oppdrettsnæringen
Laboratorium med lang erfaring og høy kompetanse på mikrobiologiske og kjemiske analyser av næringsmiddel, vann og miljø. 6718 Deknepollen, tlf: 57 85 35 11, lab@matmiljo.no www.mat-miljo.no Akkreditert laboratorium etter NS-ISO/IEC 17025
drift på nyanlegget, vil dei kunne tilby dette. Også andre fagområde ser dei som aktuelle å gå inn på. Som til dømes produksjonsteknikk, logistikk- og administrasjonsfag.







– Det er ikkje lett å spå om framti da. Men det som er sikkert, er at vi får behov for ny kompetanse i åra som kjem, og dette må vi ta høgde for. Vi har og ambisjonar om å kun
ne bli ei traineebedrift, fortel Fære strand.

15 Hav av moglegHeiter 2022
Egil Kristian aardal
SKIPSDESIGN, INGENIØR- OG KONSULENTTENESTER MULTI MARITIME UTVIKLAR: • kostnadseffektive og miljøvenlege forbåtar, brønnbåtar og servicefartøy • miljøvenlege flytande lukka oppdrettsanlegg (FLO) for norske fjordar A til Å www.atilaa.no www.multi-maritime.no
Starta PÅ golvet: – At mange utdannar seg, er med på å heve kvaliteten på arbeidet vårt, fortel Natalia Kazantseva, som snart er i mål med fagbrevet sitt. F oto : e gil a ardal
Med rosa dekk og isgrønt styrhus merksemd frå dei reiarlaget gjerne

16 Hav av moglegHeiter 2022
F oto : a ND rea lYN g
Stolt: Rebekka Lyng er marknadssjef i Babord Group AS. Ho er stolt over profilen selskapet har og no også viser fram på fiskebåten «Rebekka L».
styrhus får fiskebåten «Rebekka L» gjerne ser fleire av på havet
Raudebe Rg: Babord Catch AS sin nyaste båt, «Rebekka L», er første båt ut som er måla i konser net sine profil-fargar sjøgrønn, isgrønn og lakserosa. Samtidig gir rosa dekk og isgrønt styrhus signal om ein arbeidsplass som ønsker mangfald.
– Vi har ønskt å gjere dette sidan vi fornya profilen vår i 2018. Mange ser på det som eit utradisjonelt de signval, noko vi trur handlar om fargevalet. Vi gjekk nokre runder, både for å finne riktige fargar, men også på om vi skulle sette prikken over i-en med det rosa dekket, smi ler Rebekka Lyng, båten si namne mor og marknadsdirektør i Babord Group.
Om nokon har tenkt at dette er ei kortvarig Rosa sløyfe-markering el ler eit innslag i debatten om trakas sering av kvinner på fiske, så tar dei feil. Med profilfornyinga i 2018 byg de Babord Group si merkevare på kystkvinna og den viktige jobben ho har stått for. No målar dei båtane etter selskapet sin profil, og «Re bekka L» er først ut.
– Vi ville bli lagt litt ekstra merke til, seier Lyng.
I tillegg til nye «Rebekka L» eig og driv reiarlaget Babord Catch fiske båtane «Andrea L», «Victoria May», «Gambler» og «Ringbas».
Heidrar kystkvinna
Og merksemd har det blitt, spesielt frå jenter og kvinner.
– Det er jo nettopp dei vi gjerne skulle hatt fleire av på havet, seier Lyng, sjølv om ho forklarar at dette faktisk ikkje var tilsikta då dei jobba fram profilfargane.
– Men om vår identitet og vårt fargeval kan vere med på å bane veg for ein enklare kvardag om bord, og få fleire kvinner på havet, er vi glade for det.
Lyng forklarar at selskapet sine verdiar er bygd rundt det å gi hon nør til sterke menneske som ikkje alltid har fått fortent heider.
– Frå gamalt av stelte fiskarkone ne hus og heim, medan mannen var på sjøen. Den dag i dag er det mange som framleis gjer ein stor innsats kvar einaste dag, kvinne som mann, utan at dei nødvendig vis blir hylla for det.
leitar etter rett person, ikkje rett kvinne eller mann Det er likevel ikkje slik at det rosa dekket betyr at Babord berre jaktar kvinneleg arbeidskraft.
– Nei, vi er opptatt av å finne rik tig person på riktig stad og riktig ar beidsområde. Men med det fokuset som i dag ligg på likestilling og mangfald, er det ikkje utenkeleg at vi med vår profil kan vere eit posi tivt bidrag inn i den debatten. vil vise fram moglegheitene Babord veks stadig, og søker jamleg etter ny arbeidskraft. Per i dag er det cirka 300 tilsette i heile Babord Group, og i dei tre delane av selska pet Babord Seafood, Babord Catch og Babord Industries jobbar det i dag høvesvis 210, 30 og 60 tilsette.
Lyng fortel at det er viktig for dei å vere til stades på dei ulike rekrut teringsmessene og -konferansene sjølv om dei ikkje alltid har ledige stillingar.
– Her treffer vi kunnskapsrike og interessante menneske, og viser moglegheitene som rører seg i lo kalsamfunnet vårt. Plutseleg kan det dukke opp gode kandidatar som har noko bra å tilby.
Dei er også opptatt av å ha god balanse på kjønn og alder sjølv om fordelinga innan dei ulike områda framleis er noko skeivfordelt. I fis keri og verft er det overvekt av menn og innan sjømat er det om vendt.
– Målet er endå betre balanse og vi jobbar aktivt for å skape attrakti ve arbeidsplassar for alle, seier Lyng, som meiner Babord både er ein inspirerande og motiverande stad å jobbe.
– Vi har som mål å vere ein trygg arbeidsplass der du kan føle deg va retatt og respektert, og eg synst vi har blitt ein stor og fin familie. Eg trur og håpar det er er mange med meg som gler seg til gå på jobb og er stolte av jobben vi gjer.
vil opne opp for trainee stillingar
– Lykkast de i å finne den kompe tansen de treng?
– Både ja og nei. Vi tilbyr for ek sempel lærlingplassar som gjer at vi kan få dyktige og potensielle fram tidige tilsette inn på eit tidleg stadi um. Det ser vi har skapt auka inter esse. Vi får også mange søknadar frå folk generelt, og vi ønsker no å opne opp for trainee-stillingar.
Selskapet vil også vere hyperlokale, sjølv om ikkje alle som får jobb der treng å vere det.
– Vårt hovudkontor er og forblir på Raudeberg. Stabil arbeidskraft er sjølvsagt viktig for oss, men også rett type arbeidskraft med nødven dig kompetanse og kvalifikasjonar.
Sistnemnte har ikkje alltid vore like enkelt å få tak i lokalt, men vi heiar på alle som har lyst å flytte hit, smi ler Lyng.
Ho er likevel klar over at det ofte er fleire ting som må klaffe enn ber re jobb før ein vel å flytte på seg.
– For eitt år sidan opna vi ei avde ling i Bergen fordi det var nødven dig for framtidig rekruttering og drift i den veksande nasjonale og internasjonale marknaden.
Men enn så lenge er bergenskon toret også fylt av folk som opphav leg er frå Nordfjord.
– Dei brenn litt ekstra for lokal samfunnet her heime, og det er vik tig å hugse på at også desse er gode ambassadørar der ute som fram snakker heimplassen.
Svanhild Breidalen

Profil: Babord sin profil inkorporerte allereie kvinnene sin innsats på kysten. At reiarlaget no målar båtane sine i profilfargane er noko som har kome etterpå. foto : ki n D
m o D erne: Det er ikkje berre profilen Babord Group har fornya. Med «Rebekka L» sine moderne løysingar for fiske med både enkelttrål, dobbelttrål og snurrevad fornyar båten sjølve fiskeriet. foto : P etter lun D WÅge



17 Hav av moglegHeiter 2022
Brenn for lokalsamfunnet: Rebekka Lyng (t.v.) er marknadsdirektør i Babord Group AS, medan søstera Andrea Lyng jobbar deltid som trainee ved sidan av studium ved Norges Handelshøyskole. No har begge søstrene kvar sin fiskebåt oppkalt etter seg. foto : g J ert m Y restran D
m annska P : Fra venstre: Barry Lauder, Ryan Hoggart (Peterhead), Allan Birnie (Peterhead), Tommy G. Mikkelsen (Molde), Tobias Waage Johansen (Løddingen), Steffen Vollen (Fosnavåg) og Håvard Håheim Elveseter (Fosnavåg). foto : g J ert m Y restran D
Frå kontoret i Måløy har Leni for alle landets oppdrettsanlegg
Måløy: I Fiskeridirektoratet sine lokale i Måløy sit Leni-Marie Lisæter frå Kalvåg i Bremanger. Med omorganiseringa i direktoratet fekk ho frå 1. november av ansvar for tilsyn med alle landets 1.281 oppdrettsanlegg for laks.
– Det er veldig spennande, seier Li sæter, som har arbeidd i Fiskeridi rektoratet sidan 2010.
Lisæter og dei 35 som arbeider på hennar avdeling, seksjon for akva kultur, har mange nye anlegg å gje re seg kjende med.
– Når eg får miljøundersøkingar og dei berre står oppført med namn på lokalitet må eg inn i sakshandsa mingsverktøyet vårt og sjekke kvar dei ligg, smiler Lisæter.
Per i dag er ho konstituert sek sjonssjef. Bakgrunnen for dette er at det er politisk vedtatt at etter omorganiseringa i Fiskeridirekto ratet skal leiinga for dei operative tenestene skal sitte i Bodø.
i sjø og på land
I den nye jobben som konstituert seksjonssjef for seksjon for akva kultur har ho ansvar for operasjo nelle tilsyn med alle landets opp drettsanlegg i sjø og på land, og for fisk, tare og skjel.
Når det kjem til fiskeoppdrett handlar jobben mykje om å sikre anlegg mot rømming.
For alle oppdrettsanlegga samla er arbeidsoppgåvene knytt til det miljømessige fotavtrykket som oppdrett har, samt å passe på at oppdrettsselskapa held seg til løy va dei har fått.
Passar på oppdrettarane
Ein av dei som passar på at opp drettarane held seg innanfor ram mene dei har fått for tillaten pro
duksjon, er seniorrådgjevar Jonny Johnsen.
– Oppdrettarane er underlagt ein del lover og forskrifter som dei pliktar å følgje. Før dei får sette fisk i sjøen må dei sende produksjons planar, og undervegs i produksjo nen må dei sende månadlege rap portar for den reelle drifta.

Det betyr at mykje av det John sen får på sitt bord er hemmeleg og unntatt offentlegheita.
– Korleis selskap vil produsere fisk er børssensitiv informasjon. Kjem det ut, har andre moglegheit til å rigge seg etter dette.
I Vestland er det 54 ulike opp drettarar som har om lag 290 lokali tetar i sjø, som dei pliktar å sende inn driftsplanar for.
I tillegg til å kvalitetssikre planar og biomassetal, gjennomfører også avdelinga tilsyn hos oppdrettarane for å passe på at dei er innanfor gjel dande regelverk, og har system som gjer dei i stand til å ha kontroll på produksjonen.
Digitale tilsyn
Johnsen arbeider mest frå kontoret i Måløy, og som ein konsekvens av koronapandemien har ein også dri ve ein del tilsyn digitalt.

– Eg driv mest med tilsyn opp mot hovudkontor og leiing, så då har tilsyn på Teams fungert veldig godt.
Og Johnsen opplever at opp drettarane i hovudsak er lovlydige. – Dei vil sjølvsagt utnytte dei løy
va dei har fått best mogleg, og det prøver vi å legge til rette for.
Seniorrådgjevaren er eigentleg utdanna innan bedrifts- og trans portøkonomi, men har også utdan ning og bakgrunn frå Tollvesenet. No har han vore tilsett i Fiskeridi rektoratet i 11 år.
– Sjølv om vi har blitt meir spesia lisert etter kvart, er fagfeltet fram leis breitt og det alltid noko nytt å lære. Vi har i vår jobb stor fleksibili tet og fridom, men samstundes blir det stilt store krav til kvar enkelt av oss, seier Johnsen.
variert bakgrunn
Seksjonssjefen Lisæter har utdan ning i samfunnsvitskap og økono mi frå Universitetet i Bergen og Høgskulen i Volda. Og blant dei 20 kollegaane hennar på kontoret i Måløy finn ein folk med ulike bak grunnar.
Der er marinbiologar, juristar, økonomar, samfunnsvitarar, folk med akvakulturutdanning som har erfaring frå næringane og dei som jobbar med analysearbeid opp mot risikovurdering.
– Her er mykje kompetanse sam la, slår Lisæter fast, og held fram:
– Vi har ein veldig stabil arbeids stokk. Det kan av og til vere utfor drande å rekruttere, men når dei kjem inn, så blir dei verande.
Og Lisæter er langt frå den einas te som pendlar. Det er ytterlegare to som pendlar til Måløy frå Kalvåg, to frå Stadlandet og nokre frå Nord
18 Hav av moglegHeiter 2022
a llti D N oko N yt t: Jonny Johnsen har arbeidd i Fiskeridirektoratet i 11 år. F oto : maria NN e S. ro ti H a U g
Stor o PP gåve: Frå kontoret i Måløy har konstituert seksjonssjef for akvakultur Leni-Marie Lisæter i Fiskeridirektoratet mellom anna ansvar for tilsyn med alle landets 1.281 oppdrettsanlegg for laks. F oto : maria NN e S. ro ti H a U g
Ute i F elt: Leni-Marie Lisæter begynte som inspektør i Fiskeridirektoratet i 2010. I byrjinga var ho ute på anlegg og kontrollerte landingar. Vidare har ho hatt fleire roller.
F oto : P rivat

Leni ansvar oppdrettsanlegg

fjordeid, men dei fleste bur i Måløyområdet.
– Det er verkeleg ikkje noko pro blem å pendle til Måløy, men vi har også opna for meir for heimekontor etter pandemien, og det er klart at då sparar eg jo to timar på reise som eg kan bruke til noko anna.
viktig for måløy


Fiskeridirektoratet flytta inn i da gens lokale i Fiskernes hus i 1986. Og trass i fleire omorganiseringar har ein klart å halde på kontoret i Måløy. Det er Lisæter svært glad for.
– Det er veldig viktig for Måløy og regionen at vi har ein statleg ar beidsplass som Fiskeridirektoratet her. Andre offentlege arbeidsplas sar er stort sett knytt til arbeid inn an utdanning eller helse, og då er vi eit viktig supplement. Skal vi klare å få folk til området må vi har ar beidsplass til to, og her trur eg di rektoratet spelar ei viktig rolle, sei er Lisæter.
Sjølv starta ho som inspektør i Fiskeridirektoratet i 2010. I byrjin ga var ho ute på anlegg og kontrol lerte landingar. Vidare har ho hatt fleire roller.
– Dette er min tredje tittel berre i år. Før eg vart seksjonssjef for akva kultur var eg den første kvinnelege regiondirektøren i region Vest. Med omorganiseringa vart eg også den siste regiondirektøren i region Vest, seier Lisæter.
Fiskeridirektoratet blei etablert i
Bergen i 1900 og er myndigheitene sitt rådgjevande og utøvande organ innan fiskeri- og havbruksforval ting. I tillegg til tilsyn med akvakul turanlegg har Fiskeridirektoratet fleire viktige roller, og Havfors kningsinstituttet er kunnskapsle verandør til direktoratet.
Passar på livet i havet Innan resurskontroll har direktora tet mellom anna ansvar for å for midle kvotar til dei ulike båtgrup pene, ein har ansvar for fiskar manntalet, dei som har rett til å dri ve fiskeri, og ein gjer fullkontrollar på fabrikkar for å kontrollere at fangsten ein har meldt inn stem mer overeins med leveransen.
Vidare er miljøaspektet viktig i direktoratet, og ein jobbar aktivt med å samle inn garn, teiner og oppdrettsanlegg frå sjøen.
For Lisæter er forvaltningsrolla i direktoratet viktig.
– Vi skal passe på livet i havet, og ein viktig del av det er å sikre at be standane er levedyktige og at vi har mat til komande generasjonar, sei er ho, og held fram:


– Om ein ser tilbake til 60-talet så vart all silda fiska opp, og det tok lang tid før bestanden tok seg opp att. Om der ikkje er nokon som pas sar på og seier ifrå, så hadde ein fis ka til det var tomt.
Marianne SolheiM rotihaug
19 Hav av moglegHeiter 2022
t ilsette: Nokre av dei tilsette på Fiskeridirektoratet i Måløy. Framme f.v. Kari Silden Tytingvåg (seksjon for analyse og risikovurdering), Maja Finnes Sollid (fartøy og deltakerseksjonen), Kamilla Sporsheim (seksjon for akvakultur), Magne Sumstad (fartøy og deltakerseksjonen), og Leni Lisæter (seksjon for akvakultur). Bak f.v. står Tone Teigen (Fartøy og deltakerseksjonen), Kenneth Rakkenes (seksjon for fiskerikontroll) og Oddlaug Weltzien Tennebø (fartøy og deltakerseksjonen).
F oto : maria NN e s ro ti H a U g
Med ny sjarkhamn kan Robert bu i heimbygda og jobbe
Selje: Den nye flyte brygga i Lestovika utan for Selje i Stad kommu ne, vart nyleg opna av ordførar Gunnar Silden (V) etter 20 års kamp. Lokale fiskarar håper den nye brygga vil legge grunnlaget for ei større satsing og at fleire unge vil satse på havet som arbeidsplass.
To som er godt i gang med å utdan ne seg innan fiskeri, er Robert Sæ tren (19) og Marius Aam Hamre (21) frå Selje.
Begge har gått naturbruk og fiske og fangst i Måløy.
– Eg jobbar på Nesbakk og er fer dig med læretida til neste sommar. På sikt er planen å vidareutdanne meg til å bli styrmann, men akkurat
no trivst eg veldig godt som vanleg fiskar, seier Sætren.
Han er kanskje ein utypisk nit tenåring, men for han er framtids draumen å bli verande i heimbyg da.
– Eg ventar på at ein kar snart kan bygge hus til meg. Så eg har lyst til å bu i Selje, seier han.
Marius Aam Hamre går på Fags kulen Vestland avdeling Måløy der han vidareutdannar seg til å bli styrmann.
Han ser ikkje bort ifrå at også han kan bli verande i bygda. Den nye hamna er i alle fall eit godt argu ment seier han.
– Det er det. Eg har vurdert å kjø pe meg ein liten sjark ein gong – til å begynne med. Men før det blir det hus, seier han.
e inaste moglege plassering
Området der den nye brygga er lagt ut har lenge blitt omtala som det ei naste reelle alternativet for fiskara ne. Lestovika ligg sørvendt og i le for sørvesten, og har i mange år
blitt brukt som ei trygg hamn for både fiskarar og andre næringar på havet.

Sidan kailengder har vore av grensa har det vore førstemann til mølla-prinsippet eller at båtar har måtte fortøye i kvarandre som har vore regelen for å få plass. Men i september var den nye 60 meter lange flytebrygga på plass, og i no vember var det storstilt markering.
– Tjue års ventetid er over. Så no skal vi feire at vi endeleg har fått ein trygg plass for sjarkfiskarane på sørsida av Stadlandet, seier Stadordførar Gunnar Silden.
merkar ringverknadane allereie
Kaia har sidan 60-talet vore eigd av Årvik-familien, og i august tok Stad kommune over. Det skjedde etter at fiskarlaget i ei årrekke har signa lisert at plasseringa i Lestovika er den dei vil ha.
– Eg har vore personleg engasjert i dette lenge, så at vi no endeleg får den på plass er heilt fantastisk, sei
er Njål Aarsheim, lokallagsleiar i Nordfjord fiskarlag.
Han kan avsløre at den nye flyte brygga allereie har hatt effekt, ei ut vikling han ikkje trur vil stoppe med det første.
– I dag er det tre båtar som vil nyt te plassen fast, men det har allereie dukka opp ein ny kar som ønsker å satse og som no har kjøpt seg sjark. Han såg moglegheita til å starte for seg sjølv etter at kaia kom, så det har allereie fått ringverknadar, sei er Aarsheim.
– I tillegg har eg fått meldingar frå folk lenger sørover på kysten som har fått med seg at kaia har kome.
Ein eg prata med ville bruke den til å legge over not, så at kaia kjem til å bli brukt er det ikkje tvil om.
Ønsker ei industrihamn på sikt
Ønsket om å bygge ei ny fiskerikai i Lestovika har gjennom åra møtt motbør med argument som hand lar om at det ikkje er så mange som ønsker å satse og at behovet for å
20 Hav av moglegHeiter 2022
Snorklipping: Torsdag 10. november opna ordførar i Stad, Gunnar Silden, den nye sjarkhamna. Til venstre står Henriette Skaar, dagleg leiar i Sogn og Fjordane fiskarlag,
Robert (19) jobbe på havet



legge til rette dermed ikkje er der. Folk har sagt at dette blir som høna og egget. For er det ikkje lagt til ret te, vil dei som ønsker å satse finne seg andre kommunar å satse i.
Sjølv om den nye flytebrygga kan vere med på å halde dei som ut dannar seg til fiskarar i heimbygda og inspirerer fleire til å velje yrket, er målet på sikt eit større velfunge rande kaianlegg som gir rom for vekst.
– Det er heilt klart tanken sjølv om diskusjonanen omkring stats budsjettpratet har gjort det litt skummelt akkurat no, seier ordfør ar Silden.
Skal bruke steinmassar Tanken er nemleg at ei ny og stor fiskerihamn på sørsida av Stad halvøya skal kunne bruke stein massar frå gigantprosjektet Stad skipstunnel.

Kystverket har også ønske om å bruke det same området som an leggsområde under arbeidet med tunnelen, og området blei vedtatt
regulert til næringsområde etter at Stad kommune inngjekk eit samar beid med Kystverket.
– Går skipstunnelen gjennom som planlagt, er målet på sikt å få på plass ei større fiskerihamn for fiskarane. Naust, buder og alt ein treng for å drive fiskeri, og ikkje minst større kaier, seier Silden.


– e in god start
For Fiskarlaget er behovet dekt enn så lenge.
– Vi har jobba med dette sidan åt titalet, så akkurat no er vi fornøgde med kaia som har kome. Men vi har også fått signal frå kommunen om at det kan bli utvidingar etter be hov. Det er Fiskarlaget einig i. Dette er ein god start, seier Aarsheim.
Han ønsker også å takke kommu nen for rask saksbehandling.
– Eg vil rose Stad kommune. Det har gått utruleg fort, berre rundt eit år. Så dei skal ha ros for jobben dei har gjort.
21 Hav av moglegHeiter 2022
Hamn: Lestoneset gjer at hamna ligg i le for nordavind og vind frå sørvest. På bilde ser ein sørover til Hatlenes på motsett side av Moldefjorden.
F oto : BJØ rn eri K D ra B l ØS
g o D Start: Lokallagsleiar i Nordfjord fiskarlag,
F oto
Bjørn Erik DraBløs
Njål Aarsheim.
: P rivat
fiskarlag, og på andre sida Monica Sande, hamnesjef i Bremanger og Stad.
Foto: B JØ rn e ri K Dra B l ØS
r o B ert Sætren: For Robert Sætren (19) er draumen å kunne bu i heimbygda Selje, og ha ein jobb på havet. Med ny sjarkhamn i Lestovika nærmar han seg draumen. Foto: P rivat
l e Sto o P ning: Det er allereie interesse frå fleire fiskarar som vil ha båt og utstyr i den nye sjarkhamna. Fot o: B JØ rn e ri K Dra B l ØS
v il På H avet: Marius Aam Hamre og Robert Sætren har begge starta utdanning for ein jobb på havet. F oto : BJØ rn eri K D ra B l ØS
Steinvik har laga sin første øko-laks
Dei bestemte seg for snart tre år sidan. I 2021 blei den første smolten sett i sjøen – og for få veker sidan slakta Steinvik Fiske farm sin første produksjon av økologisk laks.
– Vi tok avgjerda om å legge om de lar av produksjonen til økologisk i år 2020, der fyrste utsettinga av økologisk smolt skjedde i 2021. Med utgangspunkt i avgjerda vi tok, vil om lag 20 prosent av vår år lege produksjon vere økologisk laks, som igjen betyr ca. 1500 tonn årleg, forklarar dagleg leiar ved Steinvik Fiskefarm, Erlend Vass botten.
Men først: Kva er eigentleg ein økologisk produsert laks? Det er det ingen heilt spikra fasit på på verds basis, då ulike produksjonsmiljø vektlegg ulike øko-aspekt i produk sjonen sin. Men for Vassbotten & Co er det desse føringane som gjeld:
n Verksemda må sertifiserast av organisasjonen Debio og følgje dei ra forskrifter og standard
n Laksen skal ha meir plass, og det betyr færre laks i kvar merd n Fiskefôret skal ha høgare andel marint innhald, og dermed mindre vegetabilske planteoljar
n Den vegetabilske delen av fôret må vere produsert økologisk
n Det kan ikkje nyttast genmodi fiserte plantar i fôret, såkalla GMO.

Når det gjeld det siste punktet, strekar Vassbotten under at slike produkt heller ikkje blir nytta i fôret til den tradisjonelt produserte lak sen.
Vil liggje i forkant
Men kva får ein oppdrettar til å leg gje om til slik drift, der kvar femte produserte laks skal vere både meir tidkrevjande og dyrare å produse re? Svaret på det er litt samansett.
– Så langt er det ikkje så mange produsentar som lagar økologisk laks. Men det finst ein nisjemark nad der ute for eit slikt produkt. Og vår vurdering er at den er veksan
de, særleg nord i Europa, seier Vassbotten, og held fram:


– På Steinvik har vi ein iver etter å utvikle oss og sjå framover. Vi vil tilpasse oss det som vi trur markna den vil ha meir av i åra som kjem. Andre grunnar er interessa i det å samanlikne og sjå om dette med eit anna type fôr og ekstra stor plass i merdane gir positive effektar for fisken. Trivast laksen meir i denne produksjonsforma, er dette viktig erfaring for oss med omsyn til kor leis vi tilrettelegg drifta vår, seier Erlend.
– Kva er prisane i marknaden på eit økoprodukt kontra tradisjonell oppdrettslaks?
– Prisen varierer. Prisen for øko logisk laks har til no vore noko be tre betalt samanlikna med tradisjo
nell laks. Det bør den også helst vere, då det er vesentleg dyrare å produsere i denne produksjonsfor ma. Fôret, som er den største kost nadsdrivaren, har ein høgare pris.
Har prøvesmakt
– Viss økologisk produksjon er meir plasskrevjande – kan den då ha ei framtid viss utviklinga går mot meir produksjon i lukka anlegg, dels på land?
– Eg kjenner ikkje spesifikt til re glementet her. Men om det er same kravet til tettleik her som i sjø, vil eg tru at dette vil legge beslag på kapasitetsutnyttinga til oppdretta rane. Det er, slik eg forstår det, ve sentleg mindre volum i eit kar på land og i dei fleste lukka anlegg om ein samanliknar dette med ei merd i sjø. Om kravet til tettleik er det same, trur eg at den økologiske pro duksjonsforma fort blir dyr å gjen nomføre og ikkje økonomisk bere kraftig. Det vil seie at det fort kan bli dyrare å produsere øko-laksen enn kva ein får betalt for den i marknaden. Men det blir førebels litt synsing frå mi side, strekar Vass botten under.
– Somme hevdar økolaksen har ein meir distinkt laksesmak, kan skje meir lik villaks. Har du smakt den sjølv, og kva synest du?
– Vi slakta det første partiet for nokre veker sidan, og då hadde vi ein liten smakstest internt i bedrif ta. Det var blanda tilbakemeldingar på om denne laksen skilte seg ut. Konklusjonen var i alle fall at den var veldig god!
Svend Arne vee
22 HaV aV moglegHeiter 2022
ei N aV F em : Steinvik Fiskefarm tek sikte på å leggje om 20 prosent av produksjonen sin til økologisk laks. Her blir den første generasjonen av øko-laks gjort klar for slakting. F oto : Stei NV ik Fi S ke Farm
V il ligge i F orka N t: Dagleg leiar av Steinvik Fiskefarm, Erlend Vassbotten.
Foto: P ri Vat
er H a N a NN lei S? Meir fiskesmak, og noko raudare i kjøtet. Det er dommen til fleire som har testa ut økologisk produsert laks.
Knutepunkt Florø
Florø hamn er ei miljøvenleg pulsåre som knyt regionen vår til verda, eit naturleg bindeledd mellom veg og sjø. Ei aktiv hamn, pulserande av liv og røre, med passasjerbåtar, containerfarty, supplybåtar, fiskefarty, brønnbåtar og fraktebåtar












Blir du med på laget?
Vi er Bulandet Miljøfisk AS
Som er eit innovativt akvakulturselskap som produserer laks på land.


I tillegg til driftsorganisasjonen i Bulandet har vi kontor i Florø og Leirvik i Sogn.



Vi er eit lite og samansveisa lag som har det lærerikt og kjekt i kvardagen.
I pilotanlegget skal vi produsere om lag 1200 tonn laks i året.






Og det vi lærer her skal vi bruke til å oppskalere det vi driv med i åra framover. Dette var litt om oss.





Kven er du?
FLORØ HAMN
wwwflorohamnno
Du er kanskje under utdanning eller har erfaring frå akvakulturnæringa. Eller kanskje tenkjer du at dette kunne vore interessant å være med på litt lenger fram i tid.
Uansett - ta kontakt slik at vi veit om kvarandre og kan bli betre kjent.
Ta kontakt! Det er berre å sende ein e-post eller ringe. hans@miljofisk.no, tel. 414 46 452
23 Hav av moglegHeiter 2022
www.florohamn.no
som syner byen sine maritime tradisjonar. Vi leier og ut flotte moderne lokaler og møterom
til og
Oslo og Bergen · Hurtigrute · Ekspressbåt til og frå Bergen, Nordfjord og Sogn. · Regelmessige avgangar. Fugleskjærskaien – FLORØ Postboks 17, 6901 Florø e-post: hamn@kinn.kommune.no - Tlf: (47) 57 75 67 40 foto: Truls Kleiven VERLO AS 57 85 11 77 90 91 91 96 www.verlo.no Industrivarer • Spesialvarer Båtslipp • Jernvarer • Mek. verksted Engines for marine use –provides the whole range Yanmar Pleasure Boat Engines (6.6 - 342 kW) Yanmar Comercial High Speed Propulsion Engines (47 - 1341 kW) Yanmar Medium speed Propulsion Engines (374 - 4500 kW) Purpose-built marine engines Yanmar manufactured marine transmissions Class-leading fuel consumption IMO MARPOL emission compliance Salg, deler og service - utføres av ossWHEN SAFETY AND RELIABILITY MATTERS www.tugs.no · +47 995 42 444 · post@tugs.no · HARBOUR TOWAGE · OCEAN TOWAGE · ASSISTANCE · SALVAGE PART OF RR GROUP A til Å www.atilaa.no
i den nye kollektivterminalen. Florø si rolle som eit viktig knutepunkt vert i tillegg ivareteke av flyplassen, rett i nærleiken. God kommunikasjon gjer det enkelt å reise
frå byen; · Direktefly til og frå
Mette, Yngve
Daniel har aldri angra på at dei satsa på havteknologi:
– Det gir verkeleg eit hav av
Bergen: Mette Silden og Daniel Kvalheim frå Måløy og Yngve Hagen frå Deknepollen stude rer havteknologi ved Universitetet i Bergen. – Jobbmoglegheitene er spennande, mange og ikkje minst varierte, seier dei framtidige sivilingeniørane.





Alle tre oppdaga studiet litt tilfel dig då dei på slutten av vidaregåan de var på utkikk etter interessante studiar.


– Då eg såg dette studiet forstod eg at det var det eg ville. Eg er opp vaksen i ein hamneby, og har alltid vore interessert i og fascinert av ha vet, seier Mette.
– eg har aldri sett meg tilbake
Daniel, som no går fjerde året, har aldri angra på at han valde havtek nologi. Han tok realfag på vidare gåande og hadde alltid hatt ei inter esse for teknologi og problemløy sing. Ingeniør var noko han hadde tenkt på ei god stund.
24 Hav av moglegHeiter 2022
og
A til www.atilaa.no kinn.kommune.no – handlekraft på kysten GODE PÅ KLIMA OG MILJØ I Kinn tek vi vare på naturen og er klima- og miljøvennlege. ATTRAKTIV KYSTKOMMUNE Det er attraktivt å bu, besøke og drive næring i Kinn. Kystkvalitetane og kystressursane gir oss fortrinn. GODE TENESTER I ALLE LIVSFASAR Alle har det bra der dei bur, og får tenester i nødvendig omfang og kvalitet. mer enn 150 millioner fiskemiddager verden rundt Rein Design Vår høyteknologiske produksjonslinje med robotteknologi leverte i 2020 slakteriet-as.no
Studerer: Mette Silden, Yngve Hagen og Daniel Kvalheim studerer havteknologi ved Universitetet i Bergen. F oto : P rivat
moglegheiter
– Kombinasjonen av fokus på ny teknologi, eit breitt fagfelt og veldig gode jobbmoglegheiter i heile ver da var nokre av grunnane mine for å velje dette studiet, seier Yngve.
Mette, Daniel og Yngve studerer konstruksjonar og testar materiale, dei lærer å bruke programvarer som blir brukt i industrien, for ek sempel 3D-teikning, CFD-analyse og marine operasjonar. Dei pro grammerer og har laboratoriefag, der dei utfører eksperimentelle for søk i bølgetanken på Høgskulen på Vestlandet.




– Noko av det kjekkaste er testing av ulike materialar i lab’en og simu lering av korleis ein flytande vind turbin oppfører seg til havs i eit pro gram som heiter SESAM, seier Yng ve.
Mette liker 3D-modellering svært godt.
– Og å teste ut det eg lærer i marinlab’en, seier ho.
mange og varierte jobbmoglegheiter
Dei mange jobbmoglegheitene et ter studiet var også eit trekkplaster.
– Jobbmoglegheitene er store innan marin industri og forsking. Ein kan jobbe med blant anna off shore vindkraft, bølgekraft, opp drettsteknologi, subsea-installasjo
nar og ROV/AUV, forklarer Yngve.
Sjølv har han ikkje utelukka no kon av desse som framtidige områ de å søke jobb innan.
– Det viktigaste for meg er å få jobbe med noko som kan bidra til nye løysingar og innovasjon.
Daniel ser det ikkje som utenke leg at han kjem til å arbeide innan olje og gass.
– Det er også eit sterkt fokus på fornybar energi, og ein del satsing på vindturbinar, så det er også ei moglegheit for meg, seier Daniel.
i nnhaldet i jobben er viktig Både Mette, Daniel og Yngve ser det som ein moglegheit å flytte heim – så lenge dei kan finne jobbar som er spennande og interessante.
– Det er jo verkeleg eit hav av mo glegheiter i Nordfjord, og det skjer utruleg mykje spennande der. Men først må eg studere meir, seier Met te.
– Det maritime miljøet er veldig sterkt, så at det er ein jobb til meg heime er eg heilt sikker på, smiler Daniel.

– Kva må til for at de skal flytte heim?
– Draumejobben! smiler Mette.
– Først og fremst er det ein spen nande og relevant jobb. Så kjem no kre andre parameter også inn i bil
det som fritidstilbod og skuletil bod. Eg håper jo at eg på sikt kjem tilbake til Måløy og slår meg ned der, seier Daniel.
Men han trur det er lurt å ta seg nokre år der ein jobbar andre stadar og samlar seg erfaring.
– Og så tar eg med meg all den er faringa tilbake til Måløy når tida er rett for det, seier han.
Yngve er heilt einig.


– Eg har ikkje bestemt meg for kor eg skal bu i framtida, men eg ute lukkar ikkje å flytte heim. Gode jobbmoglegheiter, familie og fin natur vil nok lokke i framtida, men tida vil vise kor eg endar opp, seier han, og legg til:
– Om eg skal flytte heim må eg ha ein jobb eg kan trivst i og ein variert kvardag.
kjellrun Åsebø
Havteknologi
■ Havteknologi er eit fem år langt studium, der ein etter enda utdanning får tittelen sivilingeniør.
■ Studiet gir brei kompetanse i sentrale tema i havteknologi, der ein halvvegs studiet kan fordjupe seg i marine målesystem eller marine installasjonar.
■ Studiet gir deg forståing av havteknologi og korleis ein kan vidareutvikle havteknologi i framtida i samanheng med annan teknologi og samfunnsbehov.
Vi er stolt støttespelar for fiskeri og havbruk
25 Hav av moglegHeiter 2022
godt miljø: – Det er eit veldig godt sosialt miljø på studiet, med mange kjekke arrangement og ting som skjer, seier Daniel Kvalheim frå Måløy. F oto : P rivat
Steinar Ryland Roger Svarstad Julie Vårdal Heggøy
Vi kjenner bransjen godt og har eit stort, lokalt fagmiljø som er klare til å hjelpe deg. I lag finn vi løysingar som passar for bedrifta di. Avtal eit møte med ein av våre rådgjevarar ved å scanne QR koden til høgre, eller kontakt oss på tlf 57 82 97 00.

26 Hav av moglegHeiter 2022
Stongfi S ke: Team Seeberg er eit av 48 fiskelag i Norge som har lov å drive stongfiske etter makrellstørje. Her har dei nettopp kome i land med ei størje på 210 kilo, tatt i havet vest for Florø. F.v. Cato Tangen, John Ivar Askevold, Magnar Ulvatn, Endre Hopland og Helge Johnsen.
foto : P rivat
Meiner turistar også bør få sjansen til å oppleve eit av dei mest spennande og attraktive fiskeria i verda: – Men det må gjerast rett
Etter mange år med få makrellstørjer bol trar storfisken seg i havet utanfor norske kysten igjen. Fiskeverda sin Formel 1-fisk er berre musklar, og kan kome opp i ei fart på 80 km/t. Med andre ord: eit attraktivt fiske for sportsfiskarar og fisketuristar, og ei utfordring for reiselivet om å skape eit charterfisketilbod.
– Eg er såpass vaksen at eg kan hugse at eg som barn frå stoveglaset såg stimar av makrellstørje som fekk havet til å koke rett utanfor Kråkenes fyr. Eg drøymde om at eg ein dag skulle fiske dei med stong. Men før eg blei gammal nok var størja vekk, seier Helge Johnsen, som vaks opp på det kjende fyret ved Måløy og har drive med havfiske sidan midt på 70-talet.
Etter at bestanden kollapsa på grunn av overfiske på 50- og 60-talet har ma krellstørja dei siste åra kome tilbake i store stimar langs kysten.
Som medlem i fiskelaget Team See berg har Helge Johnsen derfor endeleg fått oppfylt draumen om å få vere med og fiske makrellstørje med stong. Han er medlem i eitt av totalt 48 spesielt utval de fiskelag langs norskekysten som har løyve frå Fiskeridirektoratet til dette fis ket.

No er det mange som spør seg om det ikkje snart bør opnast for charterfiske der betalingsvillige sportsfiskarar frå inn- og utland kan få jakte på storfisken.
e it farleg fiskeri som må gjerast rett
Leiar i Team Seeberg, Endre Hopland, meiner det å opne for charterfiske for tu ristar er ein god idé – berre det blir gjort rett.
– Makrellstørja er ein fisk som er godt eigna for charterfiske, i alle fall om ein har rett mannskap, rett skipper, og ikkje minst rett utstyr og båt. Det siste kan eg ikkje streke godt nok under, seier Hop land, som saman med resten av teamet nyleg landa ei størje på 210 kilo like utan for Florø.

Han peikar på dei enorme kreftene til makrellstørja, eller bluefin tuna som den heiter på engelsk.

– Å få ei makrellstørje på dekk med stong handlar om stor laginnsats. Det er ein utruleg sterk fisk. Eg trur ein må ha opplevd det for å forstå kreftene. Her kan det vere snakk om å dra inn 500 meter line med 14-kilos brems på snella. Der som fisken har bestemt seg for å halde seg på djupet, hjelper det ikkje å vere stor og sterk eller å ha eit aldri så kraftig snø re. Du klarer ikkje å vinsje opp ein 300 kilos fisk som har bestemt seg for å halde seg på botnen.
Og skipperen på båten speler ei viktig rolle for å fisken opp.
– Har du litt feil innstilling på bremsa på snella, så fyk du rett på havet. Dette er eit av dei farlegaste fiskeria i verda om ein ikkje veit kva ein held på med, seier Hopland.
s
kal greie ut problemstillingane
Totalkvoten på makrellstørje for 2022 er 315 tonn.
254 tonn er sett av til notfiske, resten er fordelt mellom forskingsfast, bifangst og 18 tonn til «småskala kystfiske» som dei 48 fiskelaga kan ta ut.
Team Seeberg har berre lov å fange éin fisk – til matauk. Resten av fangsten skal merkast og sleppast laus igjen i eit sam
arbeid med Fiskeridirektoratet og Hav forskningsinstituttet.
Maja Brix, reguleringsansvarleg for makrellstørje i Fiskeridirektoratet, ser for seg at direktoratet begynner å greie ut problemstillingane knytt til charterfiske på makrellstørje kommande år.
– Denne type fiske reiser mange pro blemstillingar som vi må løyse før vi eventuelt opnar opp for det. Det dreier seg om alt frå kva kvalifikasjonar ein skal krevje for deltakarane og kva utstyr ein må bruke, til kva ein skal gjere om ein fangar ein fisk som er merka. I tillegg må vi sjå på tryggleiksaspektet. Det er ingen tvil om at dette er eit farleg fiskeri, seier Brix.
– Norge er ein superdestinasjon
Ein av dei som kan mest om makrellstør je i Norge er forskaren Keno Ferter ved Havforskningsinstituttet i Bergen. Han har jobba hovudsakeleg med turistfiske og stongfiske sidan 2009, med fokus på makrellstørje dei fem siste åra.
– Det som er så kjekt er at dette fisket no blir utvikla i eit veldig tett samarbeid mellom fiskarar, forvaltning og forsking. Det er ei ekstremt god stemning i heile miljøet. Blant anna har erfaringsdelinga ført til at tida det tek å få landa ei størje har gått ned.
Ferter har tru på charterfiske etter stør je langs norskekysten, ikkje minst i om rådet Florø-Måløy-Stad-Sunnmøre.
– Størja finst langs heile kysten, frå svenskegrensa til Frøya, men er nok en klast å finne på Nordvestlandet. Med rett forvaltning har charterfiske etter ma krellstørje absolutt eit stort potensial. Norge er eigentleg ein «superdestina sjon». Det er mange som har god kompe tanse, og det er mykje fisk i havet. Når vi no snart har knekt kodane gjennom for sking, prøving og feiling, så er det grunn lag for å utvikle eit fiske, seier Ferter, som er imponert over kor positiv utviklinga har vore.
– I 2018 var det nesten ingen som had de tru på at det var mogleg å fiske ma krellstørje på stong i Norge. I år har det blitt tatt over 100 fisk og kjøtkvaliteten på stongfiska størje er veldig god.
svømte tur-retur 15.000 kilometer
Det er august, september og oktober som er hovudsesong for fiske etter makrell størje i norske farvatn. I november forlèt fisken kysten og svømmer ut i Atlante ren. Gytinga går føre seg mellom anna i Middelhavet og i Mexicogolfen.
– Ei størje som eg var med å merke utanfor Florø hausten 2020 dukka opp på same stad akkurat eit år etter. Då had de den i mellomtida vore langs kysten av Canada før den tok turen langt inn i Mid delhavet, nord til Brønnøysund og sør til Florø igjen. Den hadde reist 15.000 kilo meter i løpet av året, men enda på same plass. Vi får håpe det er eit mønster som fortset, seier Ferter.
Gjert Myrestrand
27 Hav av moglegHeiter 2022
Prøvefiske: Dette bildet er tatt under prøvefiske i regi av Havforskingsinstituttet. foto : erle ND lore N t Z e N
ag N : Det er slike gummiblekksprutar som er mest i bruk for å lokke til seg makrellstørja. fo to : erle ND lore N t Z e N
m erki N g: Her er Keno Ferter i Havforskingsinstuttet i gang med å merke ei makrellstørje utanfor Florø. foto : erle ND lore N t Z e N
Brexit:
Spådde kappfiske – fekk rett

Skipper Geir Magne



Madsen på «MS Fiske bas» seier det har om kostningar på fleire måtar at det framleis manglar ein fiskeriavta le for pelagisk fisk mel lom Storbritannia og EU etter Brexit.
I desember i fjor fortalde Madsen korleis den manglande avtalen fø rer til at flåten må starte fisket etter makrell ein månad tidlegare enn normalt, for å sikre seg fisk før den forlèt norsk sone. Han spådde kappfiske – og fekk rett. m ista verdiar for 50 millionar på to år
– Det var det same i år. Vi var heldi ge og fekk kvoten vår, men totalt står det 35.000 tonn igjen, seier han, og forklarer at det blir eit vel dig press på fiskeriet.
– Alle må gå ut samstundes og blir liggande i ein «ball» og leite. Då blir det trongt om plassen. Det var faktisk båtar som kolliderte i år. Det førte ikkje til store skadar, men det fortel noko om situasjonen for å få fatt i fisken. Det jo store verdiar det
er snakk om.
Som døme nemner Madsen «MS Christina E» frå Fosnavåg.
– I fjor hadde dei kring 3000 tonn igjen av kvoten, og i år over 1600 tonn. Sjølv om ein trekkjer frå flexkvoten på vel 400 tonn som dei kan la stå igjen til neste år, så er det ver diar for 50 millionar kroner – eller sagt på ein annan måte: Dei har mista ein heil sesong på to år. Madsen peikar også på at driftsti da blir mykje lenger; ein brukar lang tid på køyring og leiting, og det går mykje drivstoff.
– Så miljømessig er det heller ikkje bra.
– Kva signal har de fått om ei eventuell løysing?
– Det går føre seg forhandlingar no, men det ser dårleg ut for avta len for neste år også. Signala går ut på at vi må førebu oss på at det blir slik då og.
i kkje to like år
Heller ikkje nordsjøsilda har ein komme til semje om. Madsen seier «MS Fiskebas» vil gå ut i januar med håp om at dei får fiska kvoten då, så dei slepp å ligge saman med 50-60 båtar og leite etter den i juni.
– Men det veit ein aldri, for det er ikkje to år som er like.
Hastverket med å få opp fisken før den forlèt norsk sektor, går også
ut over storleik og kvalitet.

– Japanarane vil helst ha oktobermakrellen, men då er vi ute av spe let, for då er mesteparten av fisken i britisk sektor. I år har det vist seg at fisken vi leverte i august-septem ber har halde betre kvalitet enn for venta, så det har på ein måte slått positivt ut for oss. Men vi brukar kanskje to månader på noko vi nor malt brukar tre veker på. Det fortel litt.
Psykisk press for å finne fisken
«MS Fiskebas» er ferdig med sine kvotar for i år, men skipperen seier det blir eit veldig intenst fiskeri når dei må jakte makrellen slik.
– For vår del har sesongen vore hektisk, men ok. Men vi brukar my kje meir energi, både på det men neskelege plan og i reint drivstoff, enn det som er nødvendig. Det psy kiske presset på oss for å få opp kvota blir større, for gjer vi ikkje det, er den borte. Så mentalt blir det tøffare.

Ein ytterlegare grunn til at fiska rane håpar på ein avtale, er at ma krellen har mista MSC-merkinga. Det blå stempelet frå Marine Ste ward Council bekreftar at fisket er bærekraftig.
– Kjøparane, iallfall nedover i Eu ropa, er opptekne av fisken skal ha
dette stempelet. Men når bestan den blir overfiska med 200-300.000 tonn kvart år fordi kyststatane ikkje blir samde, så går det ut over mar knadssituasjonen i Europa. Så avta len er viktig, for vi ser også at be standen minkar. Så eg håpar verke leg at myndigheitene klarar å kom me til semje, avsluttar Madsen.
Liv StandaL
Vi liker å prate med folk, og er opptatt av å lære. Vi har også mye å lærebort. Prat med oss på telefon 57750000, kom innom Fugleskjærgt. 8 i Florø eller besøkoss på www.norwell.no Your source of seafood value
28 Hav av moglegHeiter 2022
Vi liker å prate med folk, og er opptatt avå lære av våre kollegaer oppdrettsbransjen. Mange tiårs samarbeid med våre partnere i næringen og kunder over hele verden har gitt oss kunnskap som andre kan ha nytte av. Vi vil være med på å utvikle kompetansen til alle som jobber med oppdrett, salg og videreforedling avlaks og ørret. Prat med oss på telefon 57 75 00 00, kom innom Fugleskjærgt. 8 Florø, eller besøk oss på www.norwell.no Your source of seafood value Helge Landøy, Landøy Fiskeoppdrett
Vi har mye å lære av hverandre www.oceanelectronics.no Ocean Electronics leverer alt av elektronikk til fartøy • Navigasjon og styring • Maritim Radio / GMDSS • Fiskeleitingsutstyr • Satellitt TV /antenneutstyr • Bruløysingar • Satelittkommunikasjon / V-Sat • Alarmsystem / overvaking • CCTV / kameraovervåking • Teknisk tegning / dokumentasjon Måløy – Florø – Bergen Telefon nr til avdelingene: Phone Måløy Dep: +47 578 52 600 Phone Florø Dep: +47 577 51 300 Phone Bergen Dep: +47 553 49
post@oceanelectronics.no
SK i PP er : Geir Magne Madsen på «MS Fiskebas» fortel om høgt press for å få fiska opp makrellkvota før fisken forlét norsk sektor og går over på britisk side. F oto : Dag Frøyen
AS
070
– Vi må ha tillit til regjeringa
Stortingsrepresentant
Olve Grotle (H) meiner mangelen på ein fiskeri avtale mellom Norge og Storbritannia gir store økonomiske og miljø messige konsekvensar. Sjølv om han meiner det er uheldig om forhand lingane dreg ut i tid, vil han ikkje kritisere regje ringa.




– Eg er verken med i eller har inn syn i forhandlingane, men er eg kjend med mange av dei negative konsekvensane av ein manglande avtale for pelagisk fisk mellom Nor ge og Storbritannia. Både dei som går på det enkelte fartøy og fiskein dustrien, seier stortingsrepresen tant Olve Grotle, Høgre sin fiskeri politiske talsmann og medlem i næringskomiteen på Stortinget.

– i kkje rasjonelt med kappfiske
Grotle var nyleg på besøk hos Nor ges Sildesalgslag der han fekk ei oppdatering på korleis fiskarane
opplever situasjonen. Han har også vore i Brussel saman med resten av næringskomitéen for å bli orientert om utfordringane Brexit gir for hei le fiskerifeltet.
Han ser det på ingen måte som rasjonelt å drive kappfiske i norsk økonomisk sone for å ta opp mest mogleg av kvoten før makrellen svømmer over i britisk sektor.
– Mange båtar klarer ikkje å ta opp kvoten si i tide, og dette går rett frå botnlinja i rekneskapen. Heile situasjonen skapar stor uvisse for alt frå investeringsavgjerder i fiske flåten til kundar i eksportmarkna den, seier han.
Ha tillit og stå samla
Stortingspolitikaren har også stor forståing for dei menneskelege ut fordringane den uavklarte situasjo nen gir.
– Både fiskarar og landindustri opplever stort psykisk press, min dre rasjonell drift og tap av store verdiar. Mangelen på ein avtale på verkar verdiskapinga både for dei mindre fiskerisamfunna og for storsamfunnet, seier han.
Grotle sitt utgangspunkt er like vel at det beste ein kan gjere i situa sjonen er å ha tillit til at regjeringa gjer det rette og klarer å løyse den ne saka.
– Dersom eg hadde sett at regje
H eldig: Stortingsrepresentant Olve Grotle meiner det er svært uheldig om forhandlingane mellom Norge og Storbritannia drar ut i tid, men det viktigaste er likevel at avtalen som til slutt blir landa blir god for norsk fiskerinæring på lengre sikt.

ringa ikkje sette inn ressursar på å finne ei løysing, ville eg gitt klar be skjed. Men utgangspunktet mitt her er at opposisjon og posisjon har same interesse – eit best mogleg
forhandlingsresultat.
Han meiner derfor ein bør vise ein samla front og ei støttande haldning.
– For meg er det viktig at vi som sit i opposisjon ikkje prøver å score billige politiske poeng på at det enno ikkje ligg føre ein avtale. Det te grensar mot utanrikspolitikk, og eg meiner vi bør slutte rekkene på tvers av partitilhøyrsle.

Han har likevel ingen problem med å forstå dei som no hevdar at situasjonen krev ei løysing.
– Det vil vere svært uheldig viss dette drar vidare ut i tid utan ei av klaring, seier han.
også ei miljøsak
Grotle peikar også på omsynet til miljø og energiforbruk som eit ar gument for å få landa ein god avtale så snart som mogleg.
– No er ikkje pelagisk sektor den som bruker mest drivstoff i fiskeflå ten, men likevel er det uheldig at ein ikkje kan få drive optimalt, ikkje minst fordi det blir stadig meir fo kus på miljø og berekraft, seier han og legg til:

– Det viktigaste er likevel at avta len som til slutt blir landa blir god for norsk fiskerinæring på lenger sikt.
Gjert Myrestrand
29 Hav av moglegHeiter 2022
Brexit:
U
F oto : g J ert m Y re S tra N d
Sentralt på kysten ligger Måløy. Havnen bærer preg av lange og stolte tradisjoner innenfor fiskeri og havbruksnæring.
Måløy er en av norges fremste havner for sjømat.
SJØMATNÆRING – INDUSTRI – TURISME –
hav
av muligheter
Vi ønsker et tett samspill med lokalt næringsliv for å utvikle Måløy til en god opplevelse for sjømatnæring, industri og turisme.
Nordfjord Havn IKS www.nordfjordhavn.no
Måløy et
fullt
Yrla (31) gjekk frå fylkeskommunen til fiskeoppdrett:
– Eg elskar å vere potet
florø: Ho elskar Svanøy, bygda, pote ter og Sogn og Fjorda ne. Men at ho skulle jobbe med fiskeopp drett hadde ho ikkje trudd for nokre måna der sidan. Møt Yrla Klein, den ferskaste medarbeidaren på Havlandet i Florø.
– Eg sat med søknaden på nyttårs aftan og lurte på kva eg eigentleg heldt på med. Skulle eg jobbe med fiskeoppdrett? Men eg tenkte at eg fekk no berre sende den inn, så kunne eg heller seie nei om eg fekk jobben.
Det er Yrla Klein som fortel om korleis det gjekk til at ho, som els kar Sogn og Fjordane, gjekk frå trygg og god jobb blant byråkratane i fylkeskommunen til å jobbe med fiskeoppdrett i Havlandet på Fjord Base i Florø. Ja, ho er litt overraska sjølv også, men lat oss først ta eit par steg tilbake i tid.

Yrla kom til Sogn og Fjordane fyl keskommune frå jobben som flykt ningkonsulent i Sogndal kommu ne. I fylket jobba ho med fleirkultu rell opplæring. Ho var sterkt delak tig i å starte opp grunnskuleopplæ ring for minoritetsspråkleg ung dom, inspirert av det Flora kom mune hadde fått til på området blei dette vidareført i heile fylket. Yrla hadde det som plomma i egget, men så kom fylkessamanslåinga.
Fiskeoppdrett? eg?
– Det var ein overgang. I Sogn og Fjordane fylkeskommune var vi ikkje så mange. Etter samanslåinga blei vi plutseleg fleire tusen tilset te. Det blei ein større organisasjon
med større avstandar, meir byrå krati og meir spesialisering. Det passar for nokon, men eg er skapt slik at eg likar å jobbe med mange ting. Eg elskar å vere potet, smiler 31-åringen.
– Så då begynte du å sjå deg om etter noko anna?
– Nei, det vil eg ikkje seie. Eg var ikkje på leit, men eg blei nok litt meir open for å kunne gjere noko anna.
I fjor dukka moglegheita til å skif te beite opp. Havlandet skulle til sette fleire, og Yrla blei tipsa om å søke. Dermed er vi tilbake der vi starta. For ho hadde ikkje tenkt at det var fiskeoppdrett ho skulle job be med. Langt ifrå.
– Då eg tok pedagogikk og fekk jobb i fylkeskommunen, tenkte eg at det var der eg kom til å bli veran de. Så blei eg tipsa om å søke på Havlandet, og eg las søknaden og tenkte at nei, det der er ikkje meg i det heile tatt. Men så snakka vi sa man, og då blei det langt meir freistande. Og jo lenger vi kom i til settingsprosessen, jo meir over tydd blei eg.
tilbake som potet
Dermed blei det byte frå den trygge og gode fylkeskommunen, til det private næringslivet og fiskeopp
drett. Men kva er det eigentleg ho jobbar med? – Eg er byråkrat i fiskeindustrien også. Eg jobbar mellom anna med den administrative biten ein får når ein bedrift veks. Havlandet var jo fem til sju tilsette i mange år. No er dei plutseleg 30. Då må ein syste matisere på ein litt annan måte. I tillegg jobbar eg med innkjøp, litt personal, litt systematisering og litt digitalisering. Eg har vore ute og halde nokre presentasjonar. Eg job bar også med å skape sosiale hap penings, det må ein også gjere litt annleis når ein er fleire. Og så får eg vere med i produksjonen ein dag i veka, og trør til der noko skal gje rast.
Ho er med andre ord tilbake i rol la som potet, slik ho likar det best. Involvert i dei fleste fasane av drif ta, og klar for å løyse dei oppgåvene som må løysast. Skilnaden frå fyl keskommunen er ikkje så stor som ein kanskje skulle tru, men noko er annleis.
– Det er mindre forskjell enn eg trudde det ville vere. Administra sjonsarbeidet er ganske likt. Sjølv om det er det private næringslivet er det strengt regulert. Det er lov krav som må oppfyllast, og sertifi seringar som skal gjerast. Det er ikkje så annleis frå det eg jobba
med i fylkeskommunen. Skilnaden er at som offentleg tilsett represen terte eg Norge og velferdsstaten. Eg kjende på det at om eg dumma meg ut råka det alle offentlege tilsette i landet. I det private representerer eg bedrifta. Om eg dummar meg ut råkar det dei, men det råkar ikkje heile det private næringslivet. Det kjenner eg litt på. Ansvarskjensla er annleis, og trykket er mindre.
e lskar Sogn og Fjordane
Samtidig kjenner ho av og til på at ho saknar oppdragskjensla. At ho er med å bidrar til velferdsstaten. For verdiar er noko ho er opptatt av. – Eg er opptatt av at det skal vere berekraftig. At fiskehelsa står i fo kus. At bedrifta skal utvikle seg. At dei har dei rette verdiane er viktig for meg. Eg kunne ikkje jobba i kva bedrift som helst, men Havlandet klikka på alle punkta for meg.
Så må det seiast at fiskeoppdrett ikkje er noko heilt nytt. Ho kom til Svanøy med foreldra sine som 11-åring, dei kom flyttande frå Ned erland, og ho har vore innom alle som driv med fiskeoppdrett på Svanøy i ei eller annan eigenskap. Sjølv om ho no bur sentralt i Florø er det Svanøy som er heime. Ho for tel at ho hadde ein fantastisk opp vekst på øya, og den bakgrunnen
30 Hav av moglegHeiter 2022
re P re S e N terar : Yrla Klein byta frå offentleg til privat, og representerar no Havlandet. Men skilnaden er ikkje så stor som
Sysselsetter over 200 personer
Mange gode jobb muligheter
har fått ho til å elske både bygdeli vet, Svanøy og Sogn og Fjordane.
– Eg elskar Sogn og Fjordane. Her har alle ein identitet frå den bygda dei er frå, det kjem nok av at vi aldri har hatt ein stor og dominerande by, i tillegg til at dei har Sogn og Fjordane. Det er ingen i Hordaland som er stolt av at dei kjem frå Hor daland. Det er stor skilnad. Her har alle vakse opp i små samfunn. Dei er vant til å ta tak sjølv, dei veit at dei må ordne opp sjølv om noko skal bli gjort. Det er ikkje hjelp i å ringe til nokon å klage. Og alle er litt sære! Du kan ikkje vere A4 og bu på Svanøy, seier ho engasjert.

l itt risikabelt?
Sjølv kunne ho aldri tenke seg å bu i ein større by. Ho meiner at om ho hadde budd i Bergen er det mindre sannsynleg at ho ville ha fått mog legheita til å byte frå offentleg byrå krati til fiskeindustrien.
– Du syntest ikkje det var risika belt å byte ut ein trygg og offentleg arbeidsplass? Du angrar ikkje?
– Jau, litt risikabelt er det. Etter samanslåinga av Sogn og Fjordane og Hordaland blei det eigentleg innført krav om master for den stil linga eg hadde. Eg er ikkje kvalifi sert lenger, så det er ikkje sikkert eg hadde fått kome tilbake. Men eg

har variert erfaring og kjenner meg trygg på at eg skulle klart å finne meg ny jobb om det ikkje hadde klaffa med Havlandet. No har eg ikkje vore der så lenge, eg starta i mai i år, men eg trivast godt. Eg får jobbe med mykje forskjellig, og veit aldri kva eg jobbar med kvar dag. Det er slik eg vil ha det!
arne hjorth johansen
31 Hav av moglegHeiter 2022
ein kanskje skulle tru.
Foto: P rivat
• Pelagia
• Pelagia
•
•
•
•
•
•
•
PELAGIA
walcon.no
Eg kunne ikkje jobba
i
kva bedrift som helst, men Havlandet klikka på alle punkta for meg.
Måløy Sildoljefabrikk
Måløy
Pelagia Måløy Sentrallager
Pelagia Måløy Health
Pelagia Selje
Pelagia Kalvåg www.pelagia.com
Produserer ca 270 000 tonn fisk
I REGIONEN
Bulandet

















































































opprettar
Florø: Det er viktig og nyttig for oss å vere tungt til stades i Florø, som har eit komplett miljø innan akvakultur, understrekar Hans Haddal.


Han er ein av gründerane og dagleg leiar i det landbaserte anlegget Bu landet Miljøfisk, som leverte si før ste gruppe med postsmolt frå pilo tanlegget i sommar. Heilt knirke fritt har det ikkje gått, sidan dei fekk problem med ei rist i sjøvatn inntaket. Konsekvensen vart at dei fekk ein del tang og tare i inntaket. Den første leveransen på noko over 300.000 postsmolt på storleik 450 gram vart effektuert ein månad før planen, fordi ein prioriterte å tøm me anlegget for å utbetre systemet. Kundar og samarbeidspartnerar er Landøy Fiskeoppdrett og Mowi i Dalsfjorden.
– At både små familieeigde sel skap som Landøy, men også verdas største opprettar Mowi bidrar gjen nom samarbeid med oss, er veldig viktig for oss. Dei har vist oss stor tillit så langt i utviklinga av Bulan det Miljøfisk, understrekar arbei dande styreleiar Knut Eikeland.
Hans Haddal meiner startvans kane er udramatiske:
32 Hav av moglegHeiter 2022
Miljøfisk
JØF i SK: Produksjonssjef Steinar Midtbø og Knut Eikeland jobbar
Miljøfisk ut frå Florø og har gode kontaktar i fagmiljøet i regionen. F oto : a rve o lav F. Sol B a KK e N Måløy vidaregåe nde skule Eg synest den erfaringa eg har fått med meg frå næringslivet er svært nyttig å ta med seg vidare. YSK/TAF er læring i praksis som gir alle moglegheiter Studietilbod i Måløy: - Naturbruk YSK (TAF) Yrkes- og studiekompetanse innafor: - Helsefagarbeidar - Akvakultur www.maloy.vgs.no Måløy vidaregåande skule YSK/TAF • Løn under utdanning Nysgjerrig? Sjå: www.maloy.vgs.no www.taf.no - Informasjonsteknologi og medieproduksjon - Teknologi- og industrifag
BU la ND et mil
for Bulandet
opprettar kontor i Florø
– Eg ser på det som skjedde som noko pårekneleg i ein innovasjons prosess. Det viktige er å drive på ein måte som gjer at vi tar godt vare på fisken. Vi er no i gang igjen med an dre innsett. Vi har så langt sett inn 200.000 smolt, og i neste veke set vi ut 400.000 til. Planen er å ta des se opp mot ein kilo levering i mars neste år. I Bulandet har vi eit veldig flott driftsteam som vert leia av Øy vind Høie, som har lang fartstid som oppdrettar i ytre Sogn. I Florø har vi også sikra oss Steinar Midtbø som produksjonssjef for å utvikle drifta vidare, fortel Haddal.
Midtbø har tidlegare jobba som produksjonsleiar for matfisk i ulike selskap fram til 2003 då han slutta i Panfish og tok til i det lokale IT-sel skapet Mercatus i Florø. Dei siste par åra har han vore produksjons sjef i Nordfjord Laks i Gloppen.
Florø-arm
Midtbø og arbeidande styreleiar Knut Eikeland skal no ha arbeids plass i Bulandet Miljøfisk sitt Florøkontor, som etter kvart vil vere å finne på Kolkaia i Florø.
– Sjølv vil eg vel halde fram livs stilen som vestlandsnomade. Eg er ein sunnmøring som bur i Bergen, men som trivst best i Sunnfjord, sier Haddal.
– Det er i Bulandet vi har ho vudaktiviteten og forretningsa dressa vår, understrekar han.
– Det er her vi har identiteten vår og i løpet av kort tid vil dette bli ty deleggjort både gjennom nytt namn og profil. I Florø kjem vi til å ha ein del utoverretta funksjonar, sidan byen ligg nær flyplass, hamn og andre viktige funksjonar. Vi ser også at det er mykje lettare å rekrut tere enkelte fagpersonar i Florø enn i Bulandet, fortel Haddal.
Akvahub
Fagmiljøet i Akvahub i Leirvik i Sogn har også vore sentralt i utvik
linga av Bulandet Miljøfisk. Haddal tok i si tid initiativet til dette selska pet for å skape ei felles FoU-avde ling for Bulandet Miljøfisk og andre mindre selskap med liknande be hov. Asbjørn Dyrkorn Løland som tidlegare var leiar i Akvahub har no gått over i full stilling som FOU-lei ar i Bulandet Miljøfisk, medan Trygve Hallberg har tatt over som dagleg leiar i Akvahub.
Bulandet Miljøfisk si utviklings avdeling vil bli styrt frå Leirvik i Sogn. Her sit til dagleg teknisk sjef
Christian Hatlem Skår og FoU-leiar Asbjørn Dyrkorn Løland. På utvi klingssida har dei sterke band mot viktige fagmiljø i Bergen både når det gjeld biologi, fiskehelse og tek nologi.
Søker på Lutelandet
– Vi jobbar på jamt og trutt og håpar at pilotdrifta vil gje oss gode svar på korleis vi kan drive optimalt og kunne oppskalere opp både i vo lum og frå postsmolt til produksjon av matfisk av laks på land. I piloten er planen å produsere inntil 1200 tonn per år.
Bulandet Miljøfisk har ein konse sjon på 5500 tonn i Bulandet. Sjølv om det er usikkert kor tid ein kan greie å realisere ein slik produk sjon, har selskapsleiinga sett inn i den berømte glaskula mot framtida og neste utviklingssteg. Dei har no inne ein søknad hos fylkeskommu nen om konsesjon for eit anlegg på Lutelandet i Fjaler med kapasitet på 50.000 tonn.
– Eg håpar alle som synest dette verkar spennande tar kontakt for ein uformell prat. Dersom det vi driv med har framtida føre seg, bør det ikkje vere areal som hindrar ut viklinga i selskapet, avsluttar Had dal.
Arve SolbAkken
Fremtiden
ligger i havet – rett under overflaten


Mowi er et av verdens største sjømatselskaper og verdens største produsent av atlantisk laks. Vår ambisjon er å produsere næringsrik og velsmakende sjømat av ypperste kvalitet til våre kunder og konsumenter. Vi dekker en femtedel av den globale etterspørselen etter atlantisk oppdrettslaks, og drivkraften vår er kontinuerlig innovasjon og viljen til å produsere laks på en stadig mer bærekraftig måte.
For å fortsette å lede den blå revolusjonen trenger vi ambisiøse og engasjerte ansatte med en lidenskap for vår næring. Vi er på jakt etter dyktige personer innen akvakultur, biologi, fiskehelse, næringsmiddelfag, teknologi, økonomi og ledelse.
Join the Blue Revolution www.mowi.no/mennesker
33 HAv Av mogLegHeiter 2022
go Dt i g AN g : Dagleg leiar Hans Haddal, driftsleiar Øivind Høie og veteran og gründer Ola Sveen er i gang med andre runde produksjon i anlegget i Bulandet Miljøfisk. Fot o: Bu LAND et miL jø F i S k
Aina-Elin er sjef på verdas største fiskefôrfabrikk
florø: Det nærmar seg eit år sidan Aina-Elin Karlsen (36) overtok som fabrikksjef på Cargill sin fabrikk i Florø. Dette er verdas største fôrfabrikk for oppdrettsfisk, med over eit hundre tilsette.

Etter tilsettinga vart det eit år med vidareutdanning, hos Swiss Institute of Feed Technology i Sveits, for å spesialisere seg innan pulverteknologi som var eit nytt fagfelt for ho. Då var ho etter kvart klar for stillinga som kvalitetsleiar i Florø og for fleire av fabrikkane i konsernet.
Ny i sjefsrolla
kvart år over 20 jenter frå niande klasse til oss, for å hente inspira sjon i når det kjem til val av yrke, seier ho.
– Eg tenker det er viktig at vi in formerer jentene om moglegheite ne som finst. Det handlar om å snu den tradisjonelle tenkemåten om kjønnsfordeling i arbeidslivet.
– Er det ein annan leiarstil med ei kvinne på toppen?
kutte bruken av fossilt brennstoff i fabrikken.
– Men slik stoda er i Florø, så er det ikkje nok tilgjengeleg kraft til vidare utbygging og omlegging.
Kraftnettet må oppgraderast. Vi kjem ikkje vidare, og det treng vi hjelp til. Dette er ein situasjon som gjeld fleire plassar i landet.
– Korleis er situasjonen med tan ke på rekruttering?
Vi møter ho i det nye administra sjonsbygget, der mannskapet er tett på ho som sit med det totale ansvaret. Det er ei kompleks opp gåve å drive ein fabrikk som leverer forpellets, i størrelsar frå 0,6 til 9 millimeter.
– Å få jobbe på ein slik plass der ein er tett på produksjonen, er jo draumejobben for meg som har bakgrunn frå prosessteknikk. Eg gjekk ut frå NTNU i 2011, som sivil ingeniør i prosesskjemi, fortel Ai na-Elin.
– d et var ein perfekt match Ho var innom olje- og gassraffineri et på Mongstad som trainee ein pe riode. I 2014 blei ho så tilsett i Ewos, som seinare vart kjøpt opp av Cargill-konsernet. Ewos er fram leis merkevara på foret, som dei le verer til oppdrettarane langs med kysten.
– På den tida venta vi vårt første barn, og med ein mann som kjem frå Florø med familie her, kan du vel seie at det var ein perfekt match at eg fekk denne jobben, fortel ho.
Dialekten avslører ikkje at ho ei gentleg kjem frå Egersund, til det er den for utvatna.
– Korleis vil du summere opp det siste året som leiar?
– Det har vore fantastisk gøy, spe sielt når ein oppnår resultat og får med seg dei tilsette som er verkeleg er motiverte. Dette er jo ein annan måte å arbeide på for meg. No skal eg få andre til å yte, men det har på ein måte falle heilt naturleg for meg. Det har nok lagt ei leiarspire i meg, fortel ho smilande.
No skal ho ha oversikt og ein fin ger med i det mest som skjer på an legget. Fabrikksjefen er bindeled det mot Cargill-konsernet. Er det noko som skal lanserast eller gjen nomførast lokalt, går det via ho.
– Det viktigaste for meg er å ha fo kus på dei tilsette her i Florø, slik at vi løftar oss saman og kjem nærare dei måla vi set oss.
vil
ha med fleire jenter
– Du har mange kvinner med deg i administrasjonen. Er dette eit be visst val?
– Cargill har eit tydeleg mål om at ein vil ha 50 prosent kvinner i leiar rollene innan 2030. Dette er kon kret, og då tek ein val for å oppnå det. Elles er vi med på prosjekt som Jenter og Teknologi. Då kjem det
– Leiarstil trur eg ikkje har noko med kjønn å gjere. Dette har sitt opphav i personlegheitstrekk og ikkje om ein er kvinne eller mann.
Å spele folk gode
– Har du nokon visjon eller idé om korleis du vil vere som leiar?
– Eg er ein open type med tydeleg forventningar, og det er ingen her som lurer på kva dei skal levere på. Eg ønsker å vere god på gje tilbake meldingar og vere inkluderande. Eg trur eg har evna til å spele folk gode, og virke samlande som resul tat av tilbakemeldingar, om dei er positive eller negative, seier ho.
I starten av november er dei på slutten av den travlaste sesongen, då alt handlar om fôrproduksjon. No går dei over til ei tid på året som er like travel, og då handlar det om blant anna å få tatt vedlikehald, gjennomføre investeringsprosjekt og opplæring.
mot eit grønt skifte
Auken i gassprisane har og fått inn verknad på dei, og gitt ein auke i produksjonskostnadene. Omleg ging til grønare drift er noko dei jobbar mot, der dei ser føre seg å
– Vi har alltid hatt god oppslut ning, når vi søker etter nye folk.
Samtidig har vi bygd opp ein veldig god grunnbase med tilsette som vi er kjempestolte av. Vi legg inn re sursar på utdanning og kursing, slik at alle er på det nivået som vi treng å vere, fortel ho.
Skryt til dei tilsette
I høgsesongen når fabrikken er i drift døgnet rundt, aukar dei be manninga og dei har ikkje hatt pro blem med å skaffe nok folk til dette.
– Vi har mange som starta karrie ren si her som lærlingar, og gjerne har to fagbrev, innan prosesstek nikk og mekaniske fag. Då får vi det eg vil kalle «superarbeidaren» og dei set vi stor pris på. Elles jobbar det folk her innan ordre, sal og lo gistikk. Eit stort mangfald oppsum mer ho, før turen går ut frå hjørne kontoret med utsikt mot havet i vest, til ny travel dag.
egil Kristian aardal
34 Hav av moglegHeiter 2022
leiar : – Å få jobbe på ein slik plass der ein er tett på produksjonen, er jo draumejobben for meg som har bakgrunn frå prosessteknikk, seier Aina-Elin Karlsen, fabrikksjef på Cargill i Florø. F oto : e gil a ardal
Når trykket blir så stort, blir ikkje fiskeriet høyrt
Rune Nilsen er lite optimistisk på fiskeri næringa sine vegner kring den aukande havvind-satsinga.
Nilsen, med 50 års fartstid som fis kar og tidlegare aktiv lokalpolitikar, kallar den kommande utbygginga av havvind «panikkarta».
– At den vil krevje areal på havet, er sjølvsagt punkt éin for oss som driv fiskeri. Områda dei foreslår å bruke til havvind er ofte dei beste fiskefelta, eller gytefelt. Til dømes ved Olderveggen og på Frøyagrun nane hadde vi ti år med sildegyting, mellom 1992 og 2002. Norsk vår gytande sild er den største fiskebe standen vi har på kloden, den har vandra langs norskekysten i all tid. Og vi veit kva silda har betydd for kystsamfunna, ikkje minst for Flo rø. Eg føler fiskerimyndigheitene er altfor slappe når det gjeld å tale fis keriets sak.
manglar tilstrekkeleg for sking
Fiskeriflåten betalar inn 1,35 pro sent av årleg fangstverdi i for skingsavgift – normalt over 500 millionar kroner. Desse pengane meiner Nilsen «dett ned i det store holet» i Finansdepartementet, når dei heller burde vore brukte til å forske på kva konsekvensar hav vindutbygginga får for fisken. I årets statsbudsjett varsla regjeringa 10 millionar til forsking på fisk og havvind.
– Ein veit ikkje om ein skal le eller gråte. Når ein då snakkar om 10 mil lionar, er her altså rikeleg å ta av.
– Havvind-bransjen har sjølv bede om at det skal stillast miljø krav og at utbygginga av havvind skal skje trinnvis og kunnskapsba sert, skreiv leiaren i Norwea, inter esse- og bransjeorganisasjon for havvind, i eit lesarinnlegg i BT i sommar. Trur du den høge straum prisen vil gjere at hastverket med å komme i gang med havvind blir større?

– Det er det som er signala vi får frå regjeringa. Men om utbygginga blir kunnskapsbasert, kjem an på kva legg ein i det. Og når ein kjem puslande med 10 millionar til for sking på påverknaden i havet, så er det jo ingenting! Skal ein få kunn skap om kva som skjer i havet, må forskinga vare nokre år, slik at ein får samanlikna. Gjerne ein tiårspe riode. All havforsking går føre seg på den måten; ein ser seg bakover og samanliknar. Vi er redde for at ein berre startar opp no, fordi tryk ket for å få meir straum er så stort.

Nilsen fryktar at med alt bråket som har vore kring vindkraft på land, vil det vere enklare å få folk med på havvindutbygging.
– Då er det av auge, ut av sinn. Men ein bør også vere klar over at
eit havvindanlegg vil vere fem gon gar dyrare enn eit vindkraftanlegg på land, så straumen derifrå vil bli mykje dyrare.
m iljøvennleg?
Nilsen fryktar også at «kunnskaps basert» helst betyr at havvindnæ ringa ser på korleis ein kan vinne ut mest mogleg straum.
– Då ein starta opp med taretrå ling for 50–60 år sidan blei det berre sjekka kor fort taren vaks opp igjen, ikkje kva verknad det hadde for li vet i havet at den blei fjerna. Så «kunnskapsbasert» er eit vidt om grep, ein må sortere kva kunnskap på jakt etter. Det roar iallfall ikkje meg når staten ikkje løyver meir enn 10 millionar til forsking. Det vitnar ikkje om stor interesse for påverknaden frå vindmøllene.
Rune Nilsen set i tillegg eit stort spørjeteikn ved miljøaspektet ved havvindparkar.
– Ein skal lage vindmøllene i
Kina, med kol og frakte dei halve jorda rundt. Sjølv var eg nyleg med og tok ned nokre veglys i glasfiber som har stått sidan 1988. Vi fekk hendene fulle av plastfliser, så små at ein ikkje ser dei, men ein kjenner dei. Alle kan sjå føre seg seg korleis det blir glasfiberkonstruksjonar i slike dimensjonar som desse vind møllene får. Då skjønar eg ikkje at dei som er på parti med miljøet kan be om havvind når dei ikkje tek med totaliteten.
– Blir det det same, trur du?
– Det veit vi ikkje, men glasfiber er glasfiber og salt sjø tærer. Dei skal også riggast ned etter 25 år og då skal dei gravast ned, slik eg har forstått det.
– Ein har gjerne funne løysingar for gjenvinning til den tid?
– Det blir dei nøydde til. Men om dei løysingane kostar pengar, trur eg ikkje dei blir brukte. Kan dei tene pengar på det, så kan hende. Men eg synest det er rett å stille desse
spørsmåla ut frå den kunnskapen vi har no.
Blir ikkje friksjonsfritt
Då Olve Grotle, havbruks- og fiske ripolitisk talsmann i Høgre, gjesta Florø i sommar, uttrykte styremed lem i Fiskarlaget, Geir Magne Røys, minimal tru på at fiskeriinteresse ne kjem til å bli høyrde i samar beidsrådet der kring 40 interesse organisasjonar skal samordne seg inn mot havvind-satsinga. Nilsen er heilt samd med han i det.
– I grunnen er det ganske enkelt –det blir litt det same som skjedde oljen kom: Når trykket er så stort, blir ikkje fiskeriet høyrt. Enkelt og greitt. Vi har ein fiskeriminister som ikkje står opp for fiskarane på dette punktet. Dette er store spørs mål, og i dei største fiskerifylka ut gjer fisket 10–12 prosent av verdi skapinga. Då er ikkje tilhøyrsla til fiskeri så stor som ein kunne øn skje, trur Nilsen, og meiner vi er historielause.
– Tenk på kva som har bygt den ne kysten – det er silda og torsken, det. Forvaltar vi desse på skikkeleg måte, kan vi ha dei i tusenvis av år. Det er viktig med ei påminning om dei er opphavet til at vi i det heile har ei kystbefolkning!
– Ser du føre deg at det er mogleg med ein sameksistens mellom fis keri og havvind?
– Det som har vore fiskeriet sin agenda, er at dei ikkje fer med dei beste fiskeområda. Vi håpar sjølv sagt at det blir teke omsyn til. Men den enorme utbygginga som har vore skissert, den ser eg ikkje føre meg kan komme utan konfliktar.
35 Hav av moglegHeiter 2022
liv standal
– Havvind-satsinga blir nok litt som då oljen kom:
SK e P ti SK: Rune Nilsen, eigar og tidlegare skipper på garnbåten «MS Skjongholm», har lita tru på at fiskarane får gjennomslag for sitt syn i prosessen med å etablere havvind. – Eg føler fiskerimyndigheitene er altfor slappe når det gjeld i tale fiskeriets sak. F oto : l iv S tandal
Stort trYKK: Den høge straumprisen kan medverke til at ein ikkje tek seg godt nok tid til å sjå på kva etableringa av havvindanlegg vil bety for livet i havet, trur Nilsen. Her frå Equinors Dudgeon Offshore Wind Farm utanfor England. Fot o: Jan a rne vold / e quinor
For Anders og Emilie gjorde programmet det mogleg å til ein spennande og relevant
Måløy: For Anders Ramsevik Kvalheim, Emilie Torheim Andal og Ole Erik Nord strand har trainee programmet til fiske eksportbedrifta Coast Seafood AS i Måløy vore nøkkelen til å starte ei karriere i sjømatnæringa.

For to av dei, Anders og Emilie, gav det også sjansen til å bygge ein spennande karriere på eigen heim stad.
– Sjømatnæringa har alltid vore ei interesse. Det ligg vel litt i blodet når ein har vakse opp her på kys ten. Då eg fekk kombinere jobbin teressene mine med sjansen til å flytte heim, var det å bli trainee i Coast Seafood ein god match , seier Ramsevik Kvalheim.
24-åringen frå Måløy studerte varehandel ved Handelshøyskolen BI før han starta eit masterstudium i maritim leiing ved Universitetet i Sørøst-Norge, som etter kvart skal bli fullført. I året som trainee jobbar han i innkjøpsavdelinga.
Han meiner blandinga av nyut danna og meir erfarne tilsette er den rette oppskrifta for å få ein god start i ein heilt ny jobb og bransje.
– Arbeidsmiljøet her er godt. Her er ein kombinasjon av folk med vel dig ulik bakgrunn og fartstid i bran sjen. Det gir ein god miks, seier han, og peikar på at det er godt å vite at ein alltid har nokon å gå til med spørsmål.
– Alle må begynne ein plass, og som trainear får vi ein mentor som har ansvar for å følge oss opp. Men
vi kan sjølvsagt også spørje kven som helst om kva som helst. Vegen til toppleiinga er kort, og sjølv om det ikkje er mange dører i kontor landskapet, så står dei dørene som er der opne om det er noko vi vil prate om.
Han trur traineeordninga i kom binasjon med eit ungt arbeidsmiljø gjer det lettare etablere seg i jobben og næringa.
– Ein får treffe folk i same situa sjon, både heilt nyutdanna og an dre unge som har kort fartstid. Ein blir kjent med folk og kjem fort i gang med å skape seg eit nettverk, seier Ramsevik Kvalheim.
– Coast var mest spennande
Med seg i 2022-utgåva av trainee programmet, som starta i byrjinga av august, har Anders med seg Ole Erik Nordstrand, som har vakse opp i Langevåg utanfor Ålesund.
Han har bak seg ein bachelorgrad i marknadsføring frå Handelshøy skolen BI og ein mastergrad frå Norges Fiskerihøgskole i Tromsø.
– Eg har nok eit ganske lidenska peleg forhold til sjømatindustrien. Eg søkte på ein del ulike stillingar, ikkje berre innan eksport, men litt forskjellig, mellom anna knytt til
forsking. Eg hadde fleire mogleg heiter, men følte at det å bli trainee i Coast Seafood var det mest spen nande, seier Nordstrand, som job bar i salsavdelinga.
Han meiner det å ha ein jobb ein trivst med er viktigare enn geogra fi.
– Det viktigaste er at eg har ein spennande jobb i sjømatbransjen. Det har eg her i Coast, så det passar perfekt.
I år er det berre Anders og Ole Erik som er trainear i Coast Sea food, og for første gang skal traine ane jobbe prosjektbasert.
– Vi jobbar i fleire ulike prosjekt som handlar om innkjøp og sal. Det gir oss ein litt mjukare overgang til det å sitte «live» i ein kjøps- eller salssituasjon og kjenne pulsen i marknaden, seier Nordstrand.
– Blås i tittelen, berre søk!
Emilie Torheim Andal vaks opp i Måløy og er utdanna lektor i Ber gen. Ho gjekk frå å vere trainee til å bli fast tilsett innan sal til den euro peiske marknaden i mars i år.
Det var reint tilfeldig at 27-årin gen blei trainee i Coast Seafood.
– Det var faren min som tipsa meg om at det var utlyst traineestil
36 Hav av moglegHeiter 2022
Heim: For Anders Ramsevik Kvalheim (t.v.) og Emilie Torheim Andal gjorde Coast Seafood sitt traineeprogram det mogleg å flytte heim til spennande jobbar. For Ole Erik Nordstrand frå Ålesund gav det moglegheita til å jobbe med noko han er lidenskapeleg interessert i. alle F oto : g J ert m Y re S tra ND
gjorde traineeflytte heim relevant jobb




lingar hos Coast. Då eg sat i Bergen og las gjennom annonsen, tenkte eg at det såg gøy ut. Samtidig var det trygt å ha lektorutdanning å kunne falle tilbake på om eg ikkje fann meg til rette.


Ho hadde ikkje heilt trua på at ho skulle få stillinga med sin bak grunn.
– Men så satsar dei jo på lokale folk, og vil gjerne at folk skal flytte heim. Ho ringte for å forhøyre seg. «Blås i tittelen på papiret, og berre søk»» var tilbakemeldinga eg fekk frå Coast Seafood då eg tok kontakt, smiler ho.
Som fersk i rolla føler Emilie at ho har fått lov å prøve seg – og også gjere feil.
– Haldninga i Coast er: Prøv deg fram, og om du gjer noko feil, så læ rer du av det.






Både Ole Erik og Emilie har vore ein del av Framtidsfylket sitt trai neeprogram, som ho meiner har gitt noko ekstra når ein er heilt ny i ein jobb.
– Ikkje minst var det fint å reise rundt med dei andre traineane som var med i programmet. Vi hadde fem samlingar der vi reiste rundt og besøkte bedrifter i Sogn og Fjorda ne. Mange hadde veldig like opple
vingar, og det var kjekt og lærerikt å utveksle erfaringar med dei andre.

vil halde fram med ordninga
Traineeordninga til Coast Seafood har vore i drift sidan 2017, og dagleg leiar Sverre Søraa meiner den har ei viktig rolle i selskapet som i ei år rekke har vore verdas største uav hengige lakseeksportør.

Selskapet hadde i 2021 ei omset ning på 4,8 milliardar og eit resultat før skatt på vel 80 millionar kroner.
– Det har vore jamn vekst i selska pet, og vi har hatt to måtar å trekke til oss arbeidskraft på. Det enklaste kan vere å annonsere etter folk med kortare eller lengre erfaring frå næ ringa. Eller vi kan ta den litt lengre vegen gjennom å ta imot nyutdan na. Vår erfaring er at traineeordnin ga har gjort det lettare å sette nye tilsette inn i vår måte å jobbe på. Ordninga har vore ein suksess, og vi kjem til å halde fram med den, seier Søraa.
Gjert Myrestrand
37 Hav av moglegHeiter 2022
Prosjekt: På hovudkontoret til Coast Seafood sit dei fleste tilsette i ope kontorlandskap. Som trainee jobbar Anders Ramsevik Kvalheim for tida prosjektbasert.
Program: Mentor for traineane er sals- og marknads-direktør Olaf Barmen (t.h.) som har eit overordna anvar for traineeordninga. – Han passar på at vi har det bra og at vi fungerer i jobbane våre, smiler Anders Ramsevik Kvalheim, Emilie Torheim Andal, Ole Erik Nordstrand. Heilt til venstre står administrerande direktør i konsernet, Sverre Søraa.
lov å gjere feil: Som trainee og nytilsett i Coast Seafood har Emilie Andal gått inn i det med kunnskapen at det er lov å gjere feil. – Haldninga er prøv deg fram, og om du gjer noko feil, så lærer du av det.
ORIGOD MEKANISK AVDELING Produksjonsavdelinga vår kan tilby eit bredt spekter av mekaniske varer og tenester. Origod AS har lang erfaring innanfor aluminium, rustfritt og syrefast. Maskinverkstaden vår har ein moderne maskinpark der vi kan utføre allsidig bearbeiding. MASKINPARK • Sveisemaskiner TIG/MIG/ MAG • Hydraulisk presse • NC kantpresser • Profil og kombisaks • Platesakser • CNC maskineringssenter • CNC dreiesenter • Dreiebenk Postboks 274, 6902 Florø • Tlf. 57 75 21 40 • www.origod.no • Brennebord • Fres • Borverk • Valse • Pulver lakkeringsanlegg • Profilvalse • Plansliper og bladslipere • 5 tonns traverskran A til Å www.atilaa.no Foto: Photoevent 940 15 823 918 08 644 Døgnbemanna vakttelefon Med vårt MH24 kort får du rabatt på hver tanking. Telefon: 57 85 36 50 | Epost: post@mhservice.no mhservice.no Fosnavåg Kulen Almenningsfjellet Moldøen Ålesund Kolset Florø Måløy Bryggja Furuholmen Klubbevika Byrkjelo Haugsbygda Utvik Leirvik Bremanger Smørhamn Sørbøvåg Dragsund Åheim Stryn Våre stasjoner:
Havlandet set nye rekordar: – Vi har aldri hatt så fin
Florø: På Havlandet på Fjordbase i Florø har dei produsert berg-gylte sidan 2014. No sprenger Henrik og resten av gjengen aller rekordar.
Lat oss ta den store nyheita først: Havlandet har aldri produsert meir berggylte enn dei gjer no. Den gam le rekorden var på i overkant av ein million leveringsklar yngel på ein produksjon. Den rekorden har dei no sprengd i fillebitar. I år produse rer dei nesten tre millionar av fis ken som er blant dei meste effekti ve våpena mot lakselus.
Henrik Posthoorn (23) frå Florø er ein av dei som har hatt eit spesielt ansvar for berggylte-produksjo nen. Han har allereie sanka erfaring frå fleire marine aktørar i området, men no er han hos Havlandet der han ventar på å få lov til å avlegge fagprøva.


– Eg var lærling på Ewos, som produksjonsteknikar. Så var eg to år hos Steinvik fiskefarm der eg be gynte på fagbrevet i akvakultur. Eg bestod eksamen i sommar, men må vente til neste sommar før eg får tatt fagprøva, fortel han.
mykje meir komplisert Havlandet fekk over hundre søkja rar då dei skulle auke staben tidle gare i år. Henrik var ein av dei ni
heldige som slapp gjennom nålau get. Det var sjansen til å jobbe med nye fiskeartar som lokka han til å søke.
– Eg såg at dei lyste ut og syntest det såg spennande ut å få prøve å jobbe med nye artar. Både torsk og berggylte, det hadde eg lyst til å prøve.
– Er det stor skilnad på å jobbe med laks, slik du gjorde før, og å jobbe med berggylte og torsk slik du gjer her?
– Absolutt! Dette er mykje meir jobb. Mykje meir komplisert. Det som skjer akkurat når torsken blir fødd er til dømes ekstremt viktig. Eg likte å jobbe med laks også, der var det meir eller mindre berre å følge med på fôringa. Her får eg vere med fisken i alle livets stadi um. Frå stamfisk, til yngel og så vi dare. Det einaste vi ikkje er borte i er slakt av fisken, forklarar han. Filosofien til Havlandet er at dei tilsette skal tileigne seg kunnskap om det aller meste som har med fis keproduksjonen å gjere. Dei skal vere litt gode på alt, i tillegg til at dei skal vere kjempegode på sitt områ
de. Når det gjeld oppdrett av torsk og berggylte er dei pionerar. Langt framme i næringa, men sjølv om dei har jobba med torsk sidan 2002, of berggylte sidan 2014, er dei fram leis langt ifrå utlært.
Fleire hender sikrar finesse
– Vi har gjort store oppdagingar, men vi lærer stadig noko nytt, seier Eivind Nordvik Hauge.
– Vi kan skrive noko på eit ark, la minere det og henge det opp, og så går det ei veke så gjeld det ikkje len ger, ler han.
Hauge er som veteran å rekne. Han hoppa over frå oljen til å jobbe med fiskeoppdrett for åtte år sidan. Også han har tatt eksamen, og ven tar på å få gå opp til fagprøva. Det er lett å sjå at han er både stolt og kry av kva dei har fått til med Havlan det dei siste åra, både med torsk og berggylte. Han fortel at produksjo nen no er på eit slikt nivå at dei ikkje har kapasitet til å auke meir.
– Kva er årsaka til at produksjo nen er så stor no, samanlikna med tidlegare?
– Først fremst er vi fleire hender.
38 Hav av moglegHeiter 2022
F ram Steg : Dei produserer meir, samtidig som fisken har det betre, seier Eivind Nordvik Hauge ved Havlandet. F oto : a rne Hjor t H j o H an S en
Kom P li S ert: Berggylte er ein komplisert fisk. Alle saman startar livet som hunnfisk. Dei som rekk å bli store og gamle nok skifter kjøn og blir til hannfisk. Dei kan blir opp mot 20 år gamle.
Foto: e ivind n ordvi K Hauge
fisk som no!
Det betyr at vi kan halde oppe fi nessen og kvaliteten på det vi gjer. Og det er ikkje berre at vi produse rer meir. Vi gjer også livet lettare for fisken i karet. Dei som har kome inn er unge og miljøbevisste. Dei vil ikkje jobbe med fisk som dør. Vi har aldri hatt så fin fisk som det vi har no!

a ldri kjedeleg
Det er nok litt meir komplisert enn at det berre er fleire hender, men dei vil kanskje ikkje røpe alle hem melegheitane til lokalavisa?
– Litt hemmeleg må det vere. Vi er langt framme og ønskjer å være i front. Samtidig er det viktig for oss at andre lykkast. Vi kan ikkje vere aleine om dette, seier Hauge.
Opphaveleg har Hauge ein bac helorgrad i turisme. Han har stu dert, reist litt rundt i verda, men alltid visst at han skulle tilbake til Florø.
– Det er ikkje aktuelt å jobbe len ger vekk enn Brandsøya, ler han, og held fram:
– Å kunne jobbe med fisk på tank nesten midt i Florø sentrum, det er

noko eg set stor pris på. Eg trivst godt her på Havlandet. Det er aldri kjedeleg, og kjem aldri til å bli kje deleg å kome på jobb forsikrar han.
i kkje tilfeldig
Det er fleire medarbeidarar på Hav landet som tek fagbrev innan akva kultur, og med det bidrar til å auke kompetansen på bruket. Isabell Skjølberg (19) er blant dei. Ho er i læretid, og skal ta fagbrevet neste år. Ho er frå Florø, men ho har levd hybellivet og gått på skule i Måløy før ho enda opp på Havlandet. Det kan ho tilrå til dei som måtte lure på om det er vegen å gå.
– Eg gjekk naturbruk og akvakul tur i Måløy og budde på hybel der. Det er kjekt å kome ut og oppleve nye miljø. Ein lærer å gjere ting på eiga hand og finne ut av ting sjølv.
– Så hamna du her på Havlandet. Var det litt tilfeldig, eller har det vore planen heile tida?
– Det var bevisst. Det var her eg hadde lyst til å vere, forsikrar ho.
Arne HjortH joHAnsen
Ny oppdaging gav vekstrekord for Havlandet-torsken
Dei endra temperatu ren på vatnet og fekk torsken til å vekse dobbelt så fort.
– Eg må berre få seie, det er ver keleg spennande det som har vore gjort på torsk i Florø, altså, fortel Erna Solberg i det ho mø ter næringslivet under eit besøk i Florø no i oktober. Ho sikta her til den innovasjo nen og nytenkinga som er så viktig for å kunne få fleire ar tar å spele på i ein bransje som dei ser føre seg skal bli femdobla i Norge på sikt. Og i Florø har dei tora å satse på torsk sjølv om det ein periode såg mørkt ut. No sit dei på avgjerande kom petanse nettopp fordi dei hadde is i magen.
utvikla på torsk, og gjere noko som aldri før har vore gjort. varmare vatn

No er Havlandet på gang med den sjuande generasjonen torsk. Dei har forbetra deg frå genera sjon til generasjon, men i den sjuande fann dei ein faktor som kan sikre at torsken veks raskare heile livet. Torsken frå den siste generasjonen var 10 gram i star ten av 2022. Den reknar dei med vil vere kring 3,5 kilo før utgan gen av året.
H jer N e N B a K: Dagleg leiar for Havlandet Marin Yngel, Halvard Hovland har lukkast. No blir torsk storskala oppdrettsfisk på land i Florø og Norge.
Havlandet er eta blert på Noregs største forsyningsbase, Fjord Base i Florø. Heilt frå tidleg 2000-tal har dei drive landbasert oppdrett av torsk her på basen. Sidan dei har jobba med torsk over så lang tid utan opphald, har dei også tileigna seg viktig kunnskap om kva som skal til for å lukkast. No sjuande generasjon på gang.
Foto: dag Frøye N
Dette er innova sjon i praksis. Det finnast ingen fasit eller lærebøker som forklarar korleis ein skal jobbe med landbasert opp drettstorsk i dag. Ar beidet til dagleg lei ar i Havlandet Marin Yngel, Halvard Hov land og resten av gjengen hos Havlan det er prega av kon tinuerleg utvikling, innovasjon og ny brotsarbeid. Dei sø ker forbetringar på detaljnivå for å oppnå den beste produksjonen og den beste fiskehelsa. Deira siste prosjekt der dei har sette på tilvekst på fisk ved ulike tempe raturar er også eit bevis på dette. Dei har oppdaga at om torsken går på varmare vatn under på vekst, vil den vekse raskare også etter at den går over på kaldt vatn.
i nnovasjon Norge
Arbeidet som har vore gjort på torskeoppdrett i Florø har vore banebrytande. Og no søker dei meir kunnskap for å kunne ta steget vidare til eit fullskala an legg. Her har dei fått Innovasjon Norge med på laget. 7 millionar har dei løyvd for å sette gang eit pilotprosjekt med produsere torsk i eit lukka RAS-anlegg. I au gust vart fisken sett inn i anleg get på Havlandet RAS-pilot og den trivast godt allereie.
Aldri før har denne teknologi en vore nytta til produksjon av torsk. Men no skal Havlandet Marin Yngel ta steget. Dei skal kombinere kompetansen dei har opparbeidd seg på laks i RAS-an legg, med kunnskapen dei har

Dette testa dei ved å la ei grup pe med yngel gå på kaldt vatn og ei gruppe først på noko varmare vatn for så gå over på lågare tem peraturar. Det tok for den første gruppa 10 veker frå å vekse frå 8 gram og til 100 gram. Gruppa som først fekk varmt vatn (11 gra der) og så gjekk over på råvatn (8,5 grader) vaks dobbelt så fort og var over 200 gram etter 10 ve ker.
– Det er alltid kjekt når testinga og prosjekta våre gir gode og ty delege resultat. Det er nyttig læ ring vi tek med oss vidare i pro duksjonen. Det vil også styrke avlsmaterialet ytterlegare, seier Halvard Hovland hos Havlandet.
DAg nesbø Frøyen
39 Hav av moglegHeiter 2022
re NS e F i SK: Berggylten sin funkjson er å ete lakselus. Difor har den ei viktig rolle å spele innanfor lakseoppdrett. Foto: e ivi N d Nordvi K Hauge
u N ge og lova N de : Isabel Skjølberg og Henrik Poosthorn har snart fagbrevet som dokumenterar at dei har den kompetansen Havlandet etterspør. Fot o: a r N e Hjor t H j o H a NS e N
B egei Stra : Leiaren i Høgre, Erna Solberg, la ikkje skjul på at ho var begeistra over det som blir gjort på oppdrett av torsk då ho var på besøk i Florø no i oktober. Bak ser vi torske-gründer Oddgeir Igland.
F ot o : dag Frøye N
100YEARS
1915-2015
Kjøpørretenvårhos

OG
overhelelandet
SkaarNorwayAS











Skaar Norway AS

Kolkaia 3 • Telefon 57 75 77 80 www.skaarnorway.com • epost: post@skaar-norway.com
Kolkaia 3• 6900Florø•Telefon57757780•Fax57757781 E-post:pit@skaar-norway.com www.skaarint.com
40 Hav av moglegHeiter 2022

Kristiansund | Førde | Skottland | Chile | Canada
Kristiansund | Førde | Skottland | Chile | Canada


























































































































































